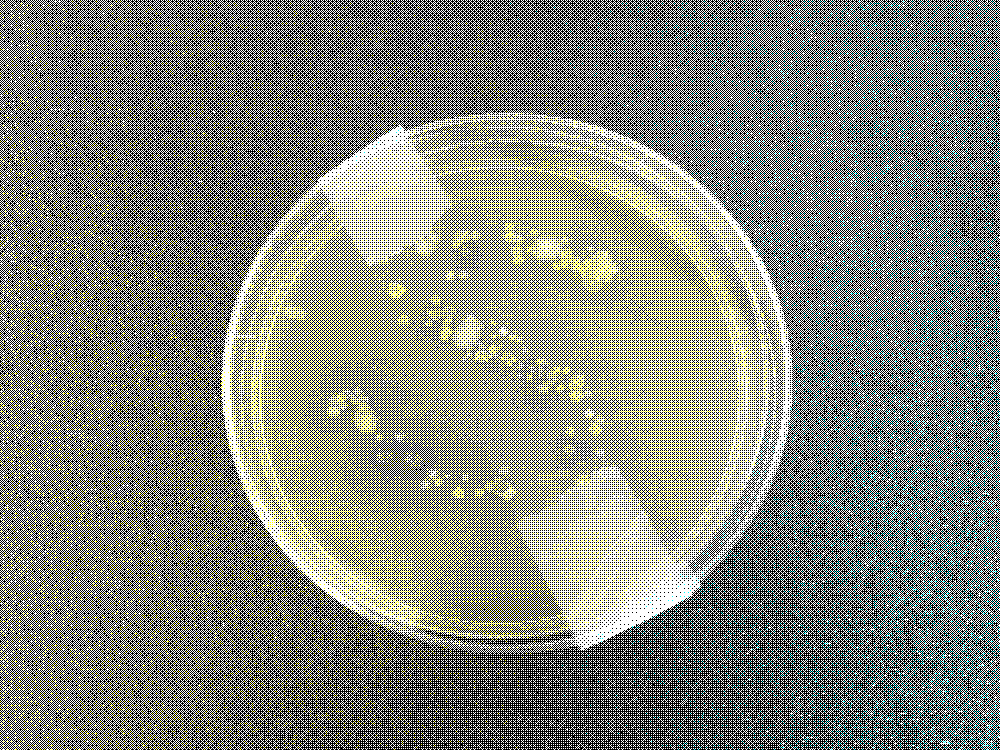
In_Contact_Komen
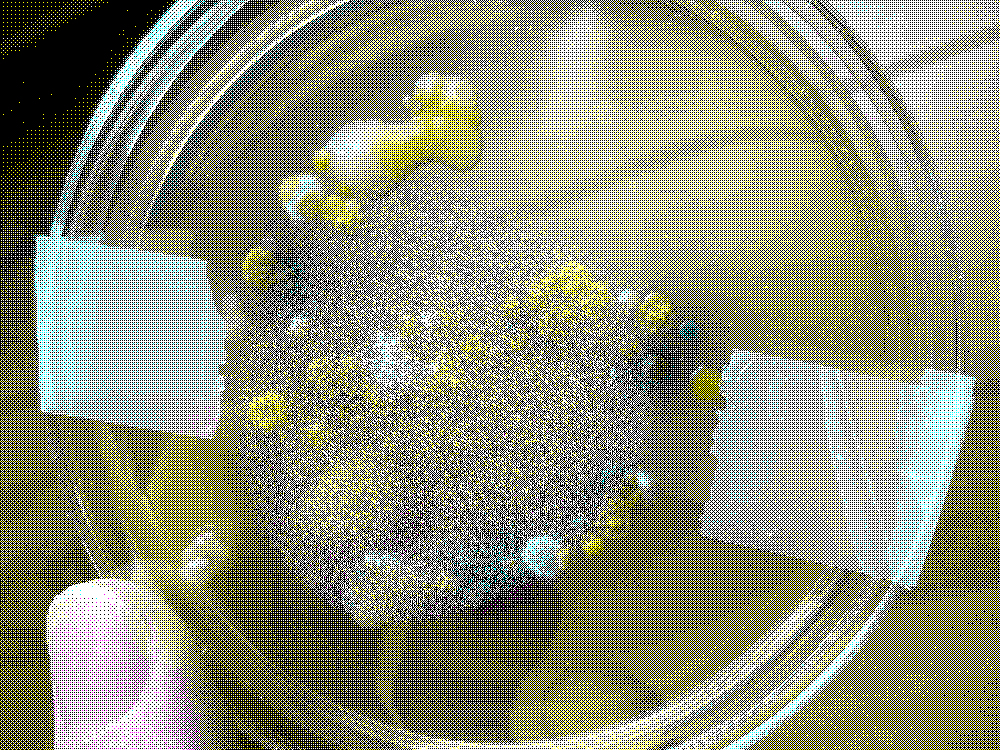
In_Contact_Komen
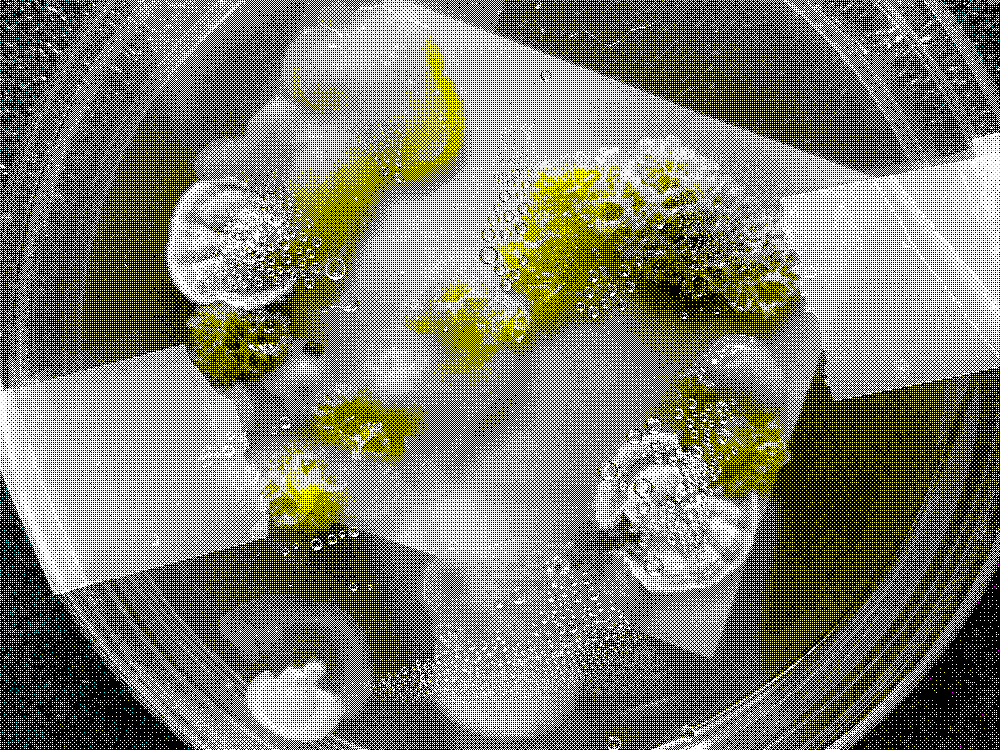
In_Contact_Komen
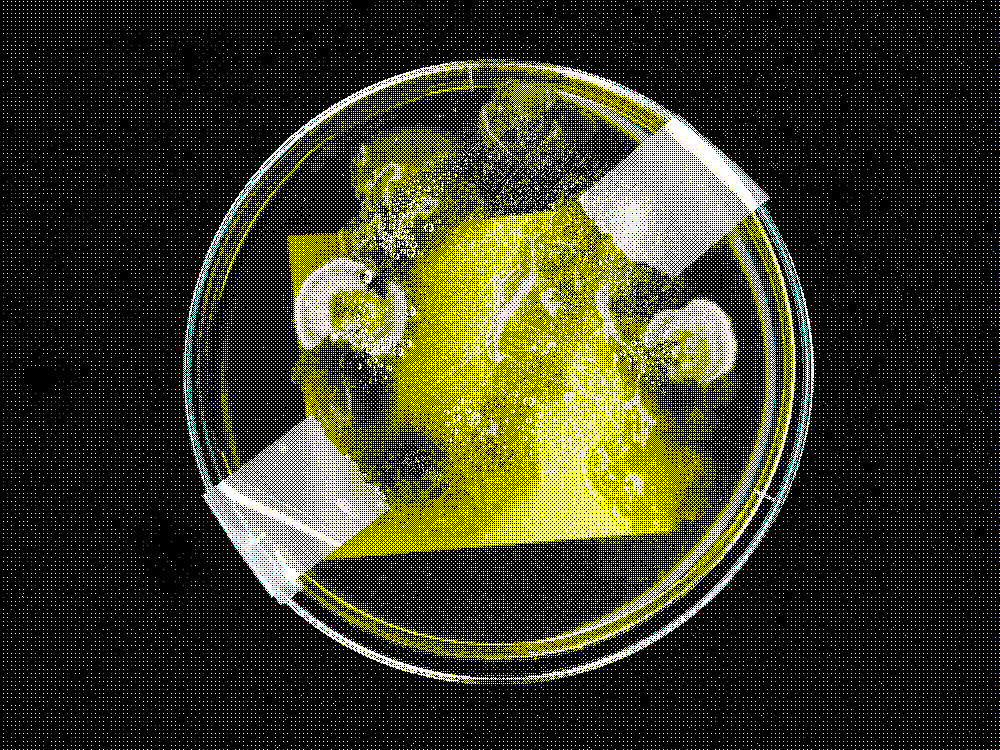
In_Contact_Komen
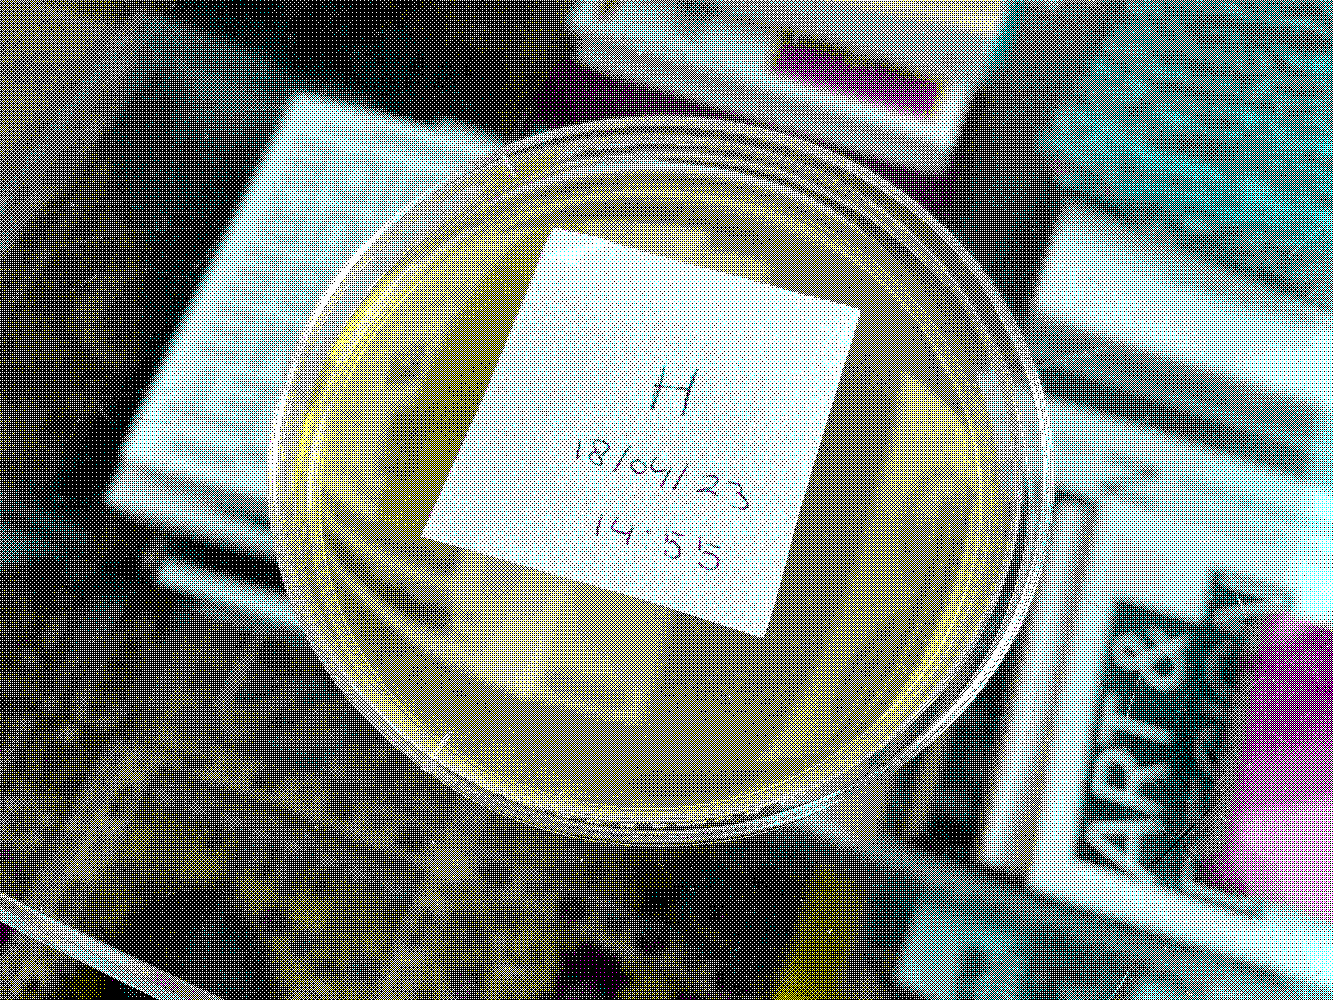
Petri-Typografie
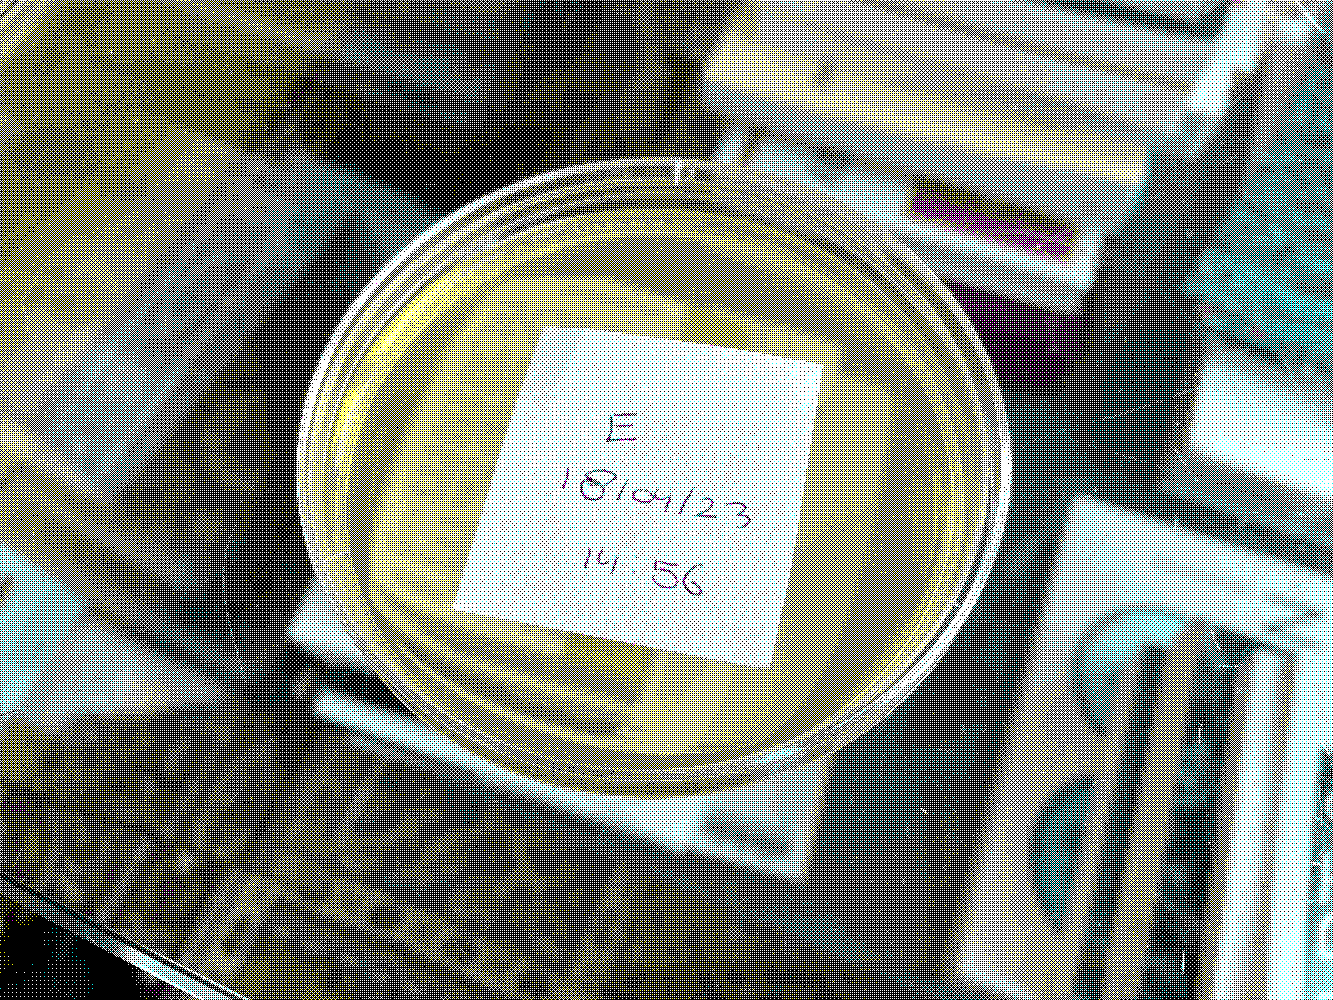
Petri-Typografie
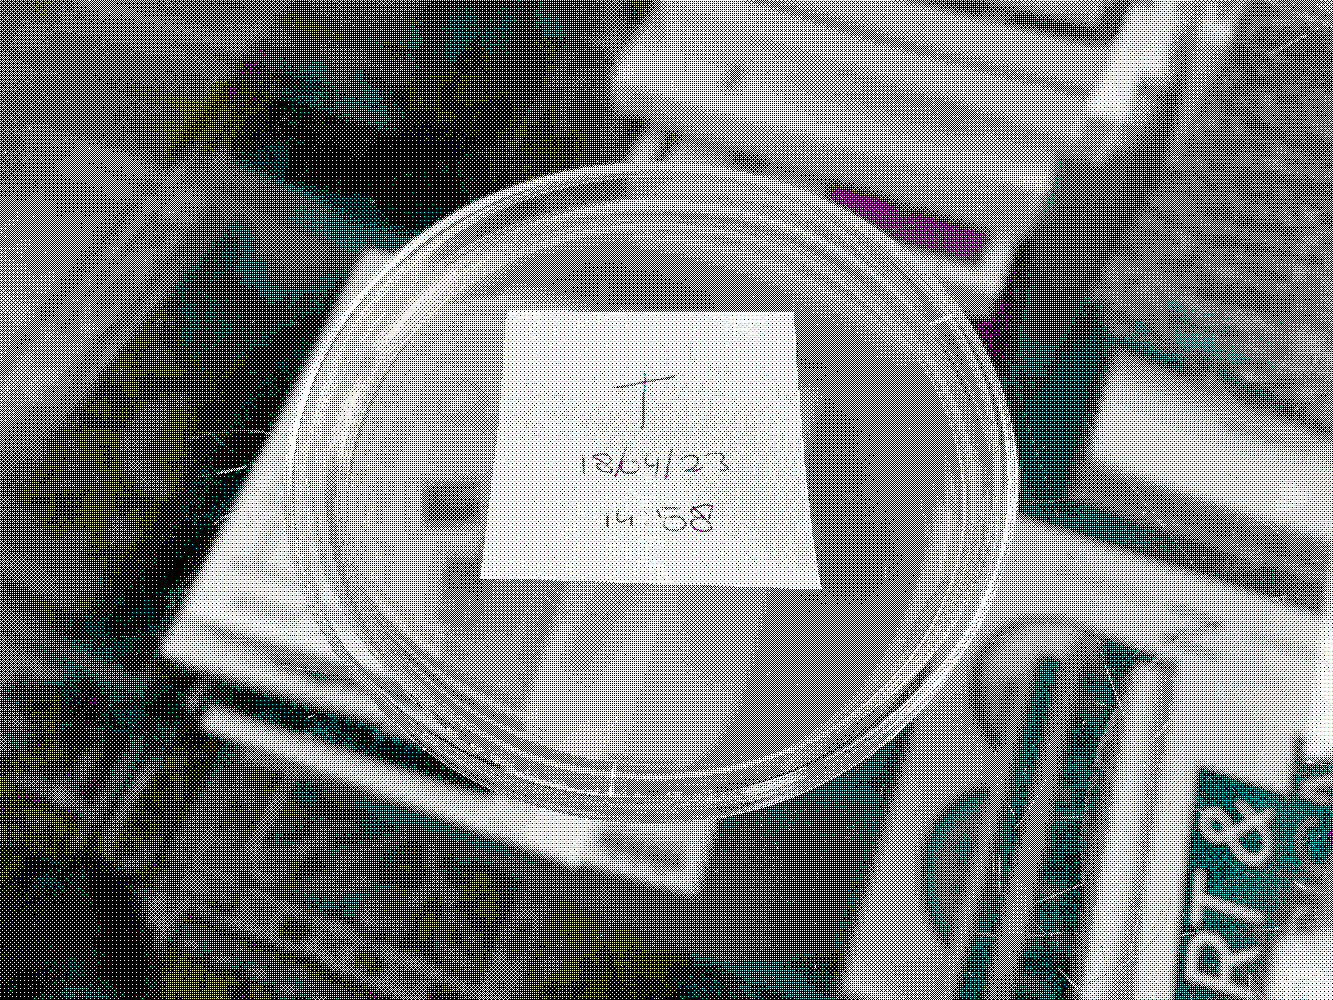
Petri-Typografie
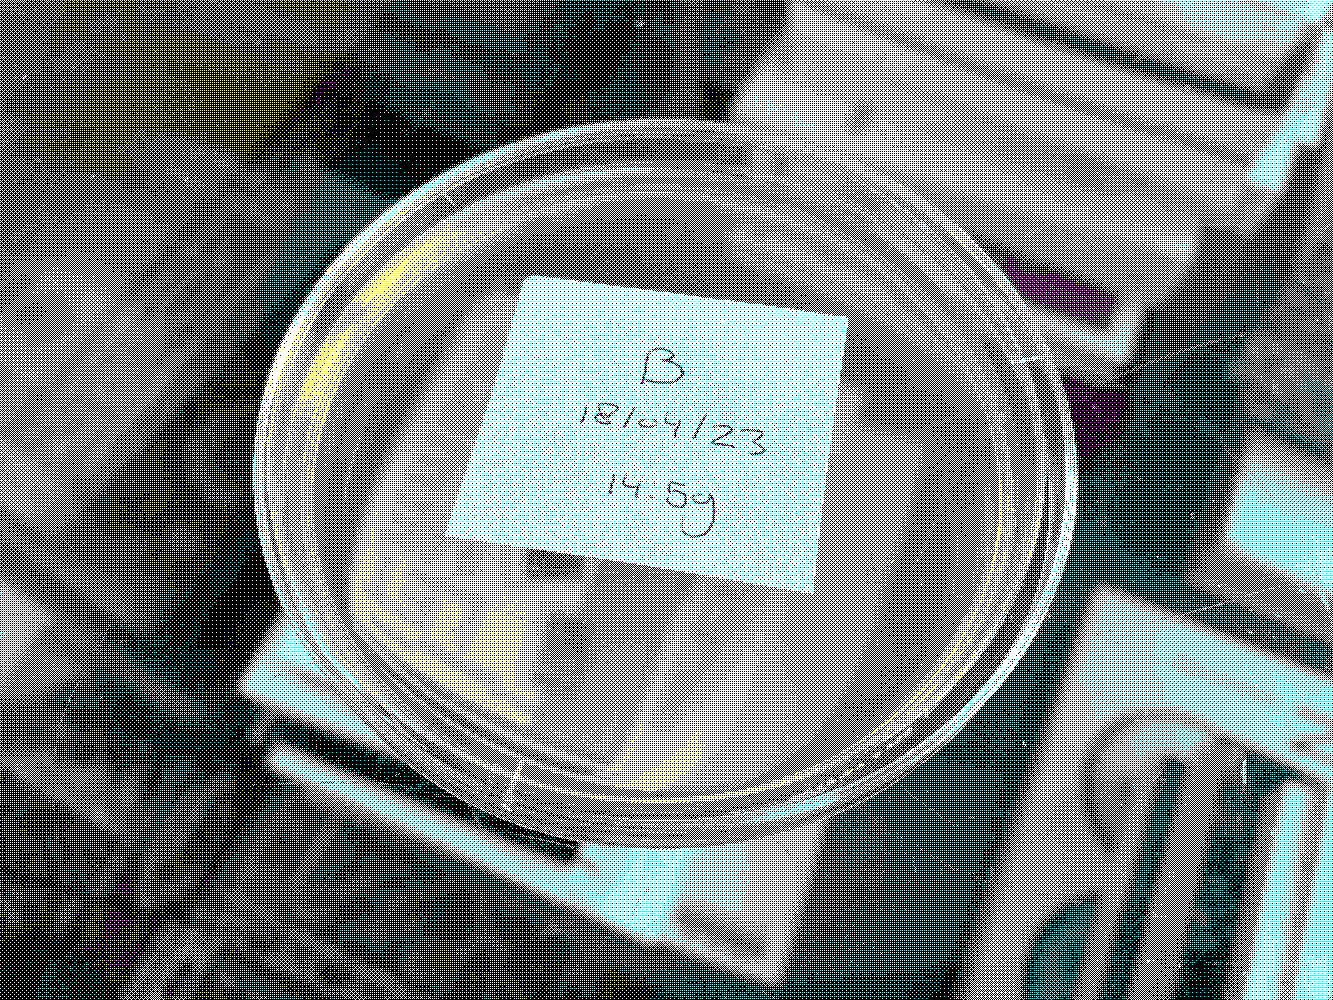
Petri-Typografie
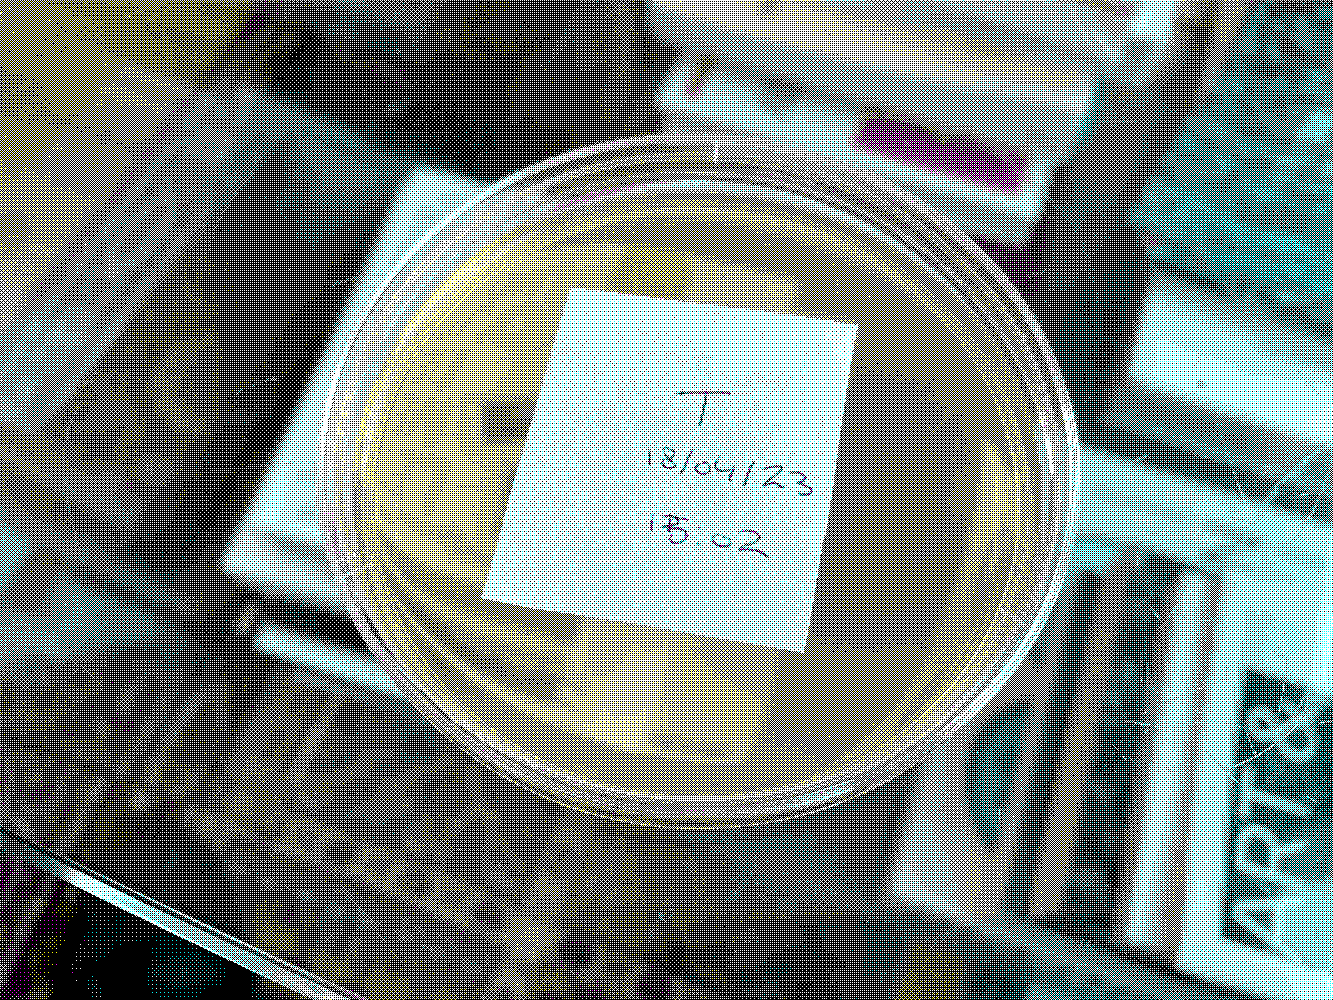
Petri-Typografie
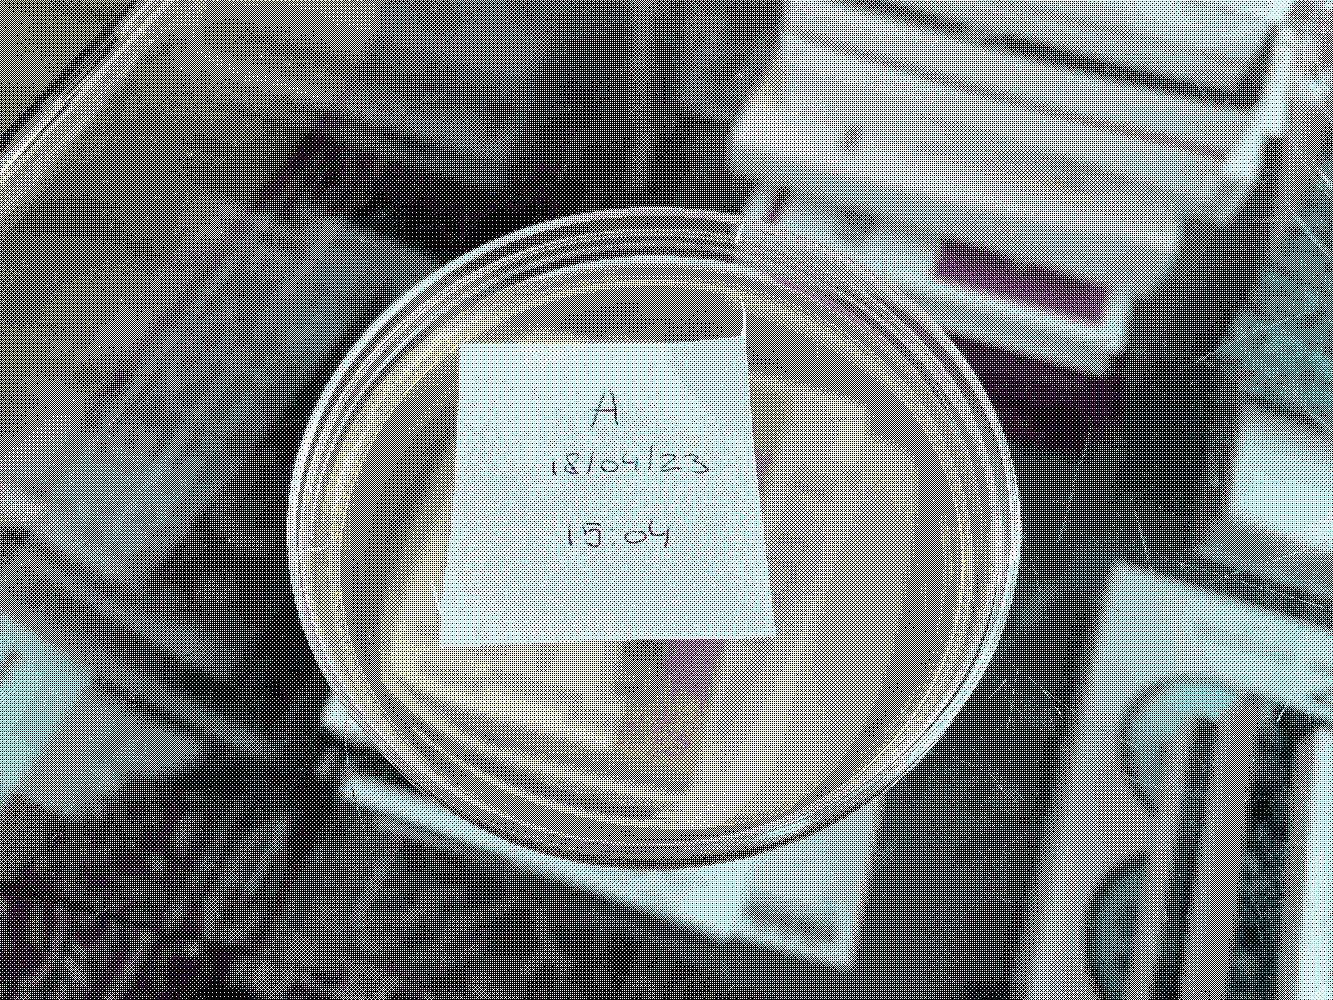
Petri-Typografie
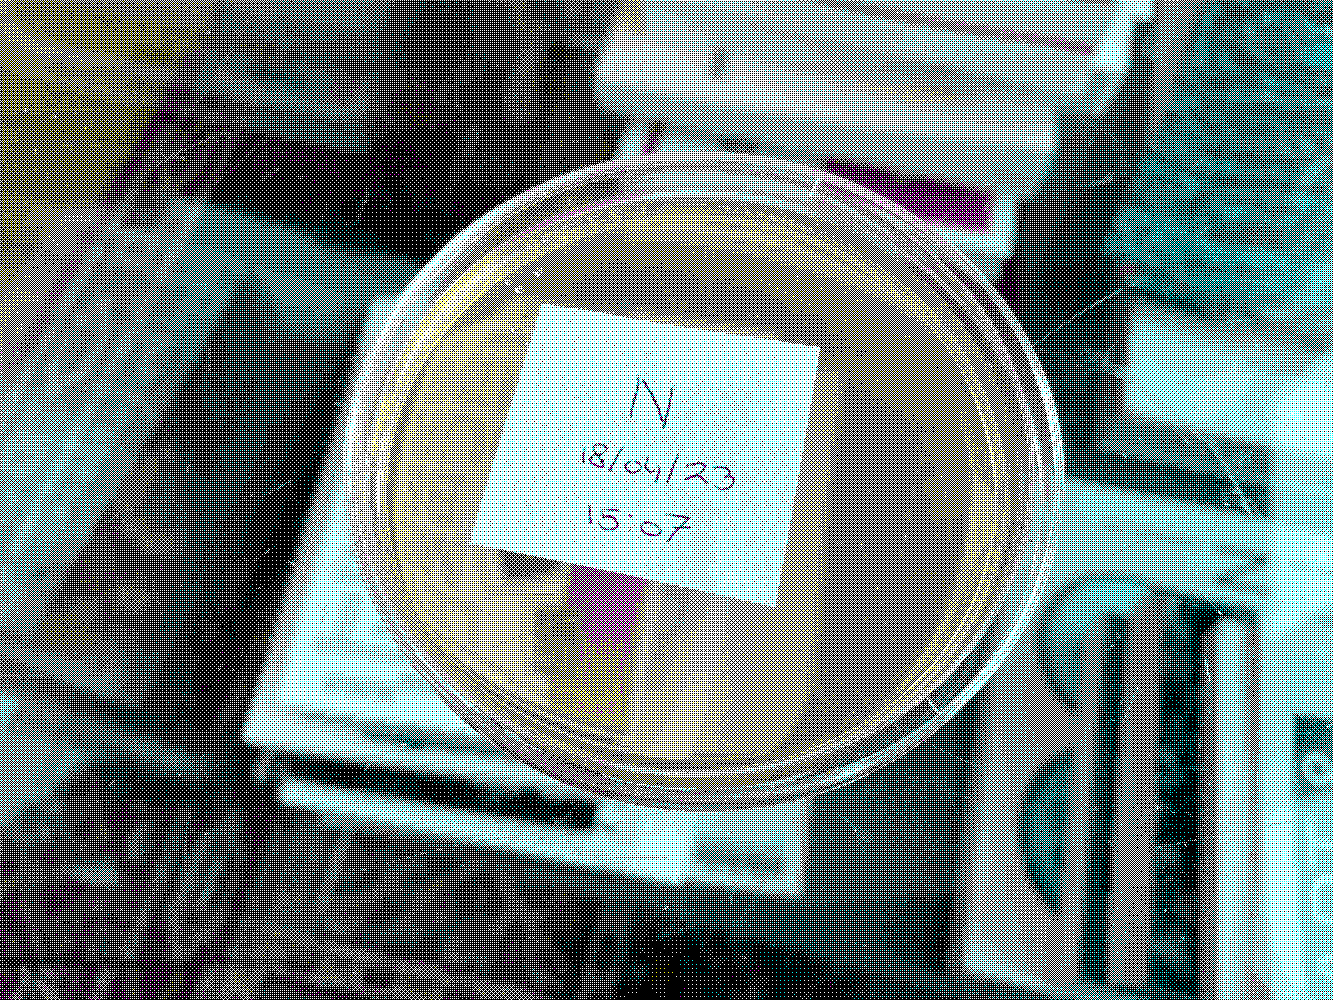
Petri-Typografie
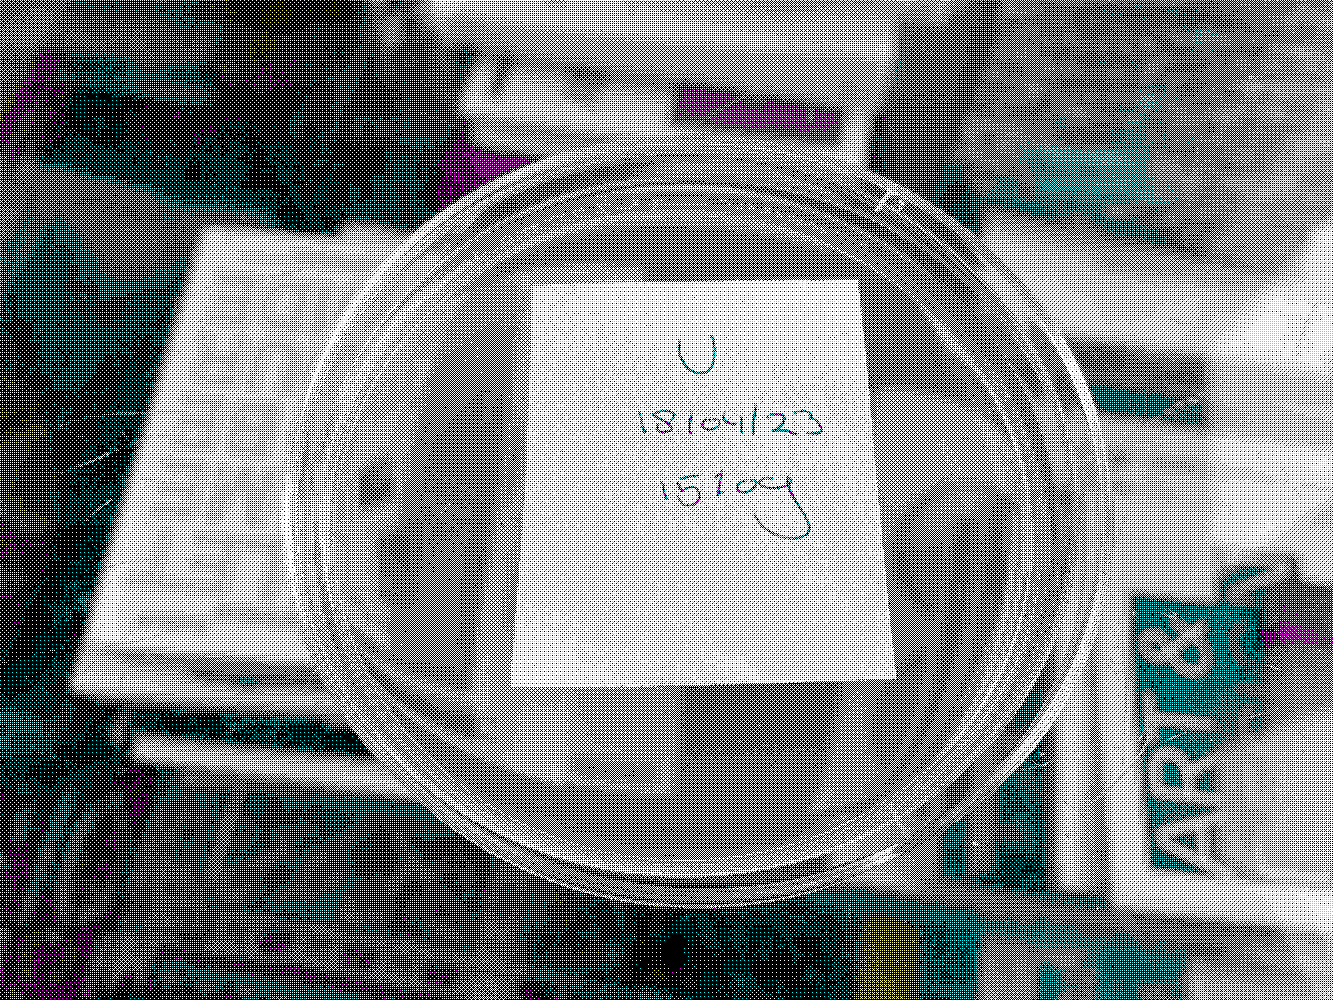
Petri-Typografie
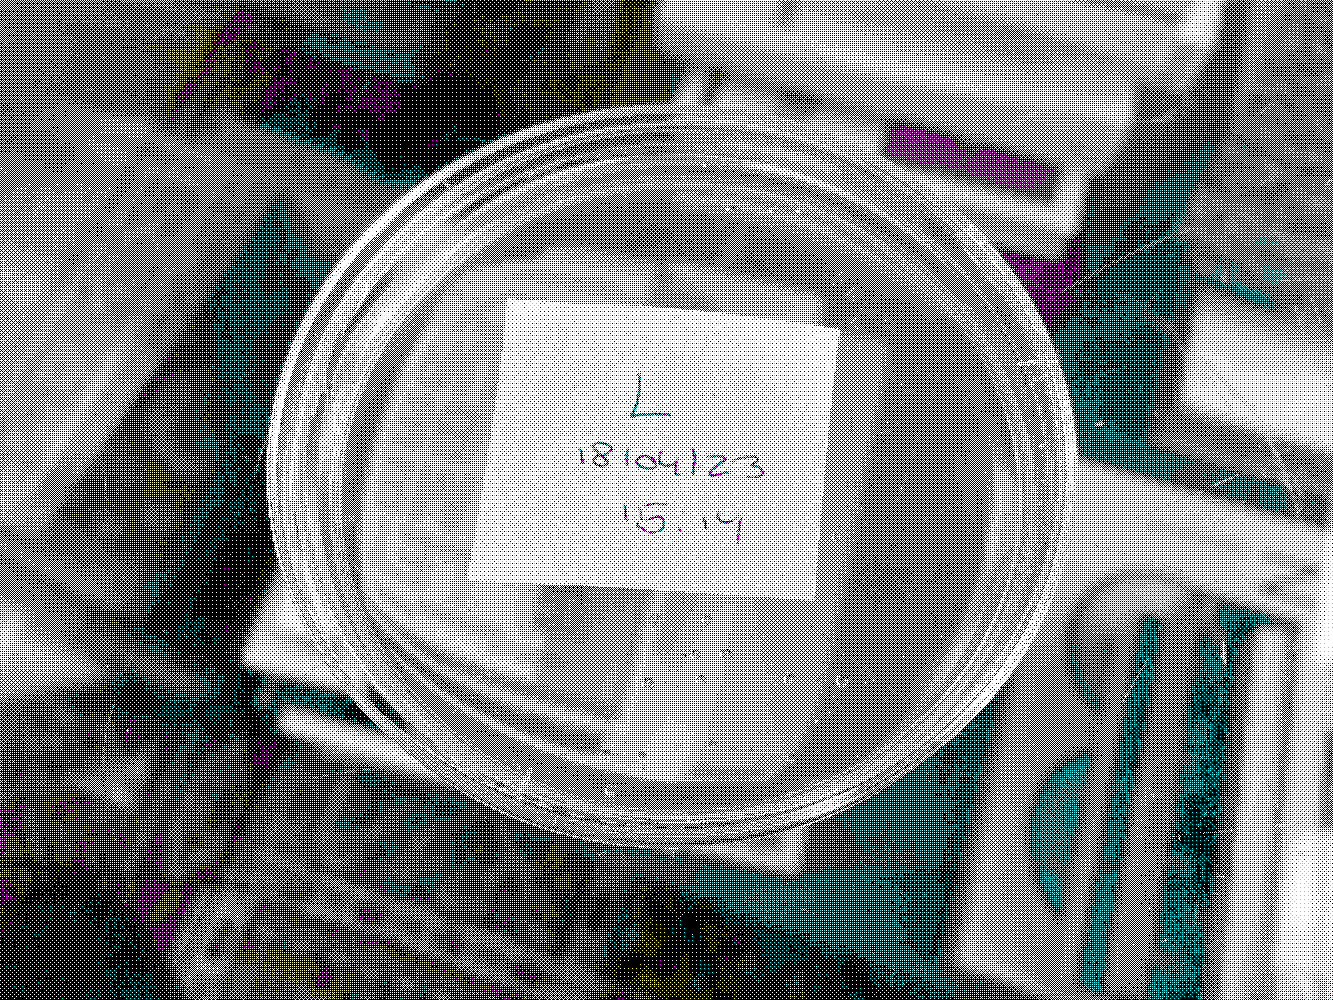
Petri-Typografie
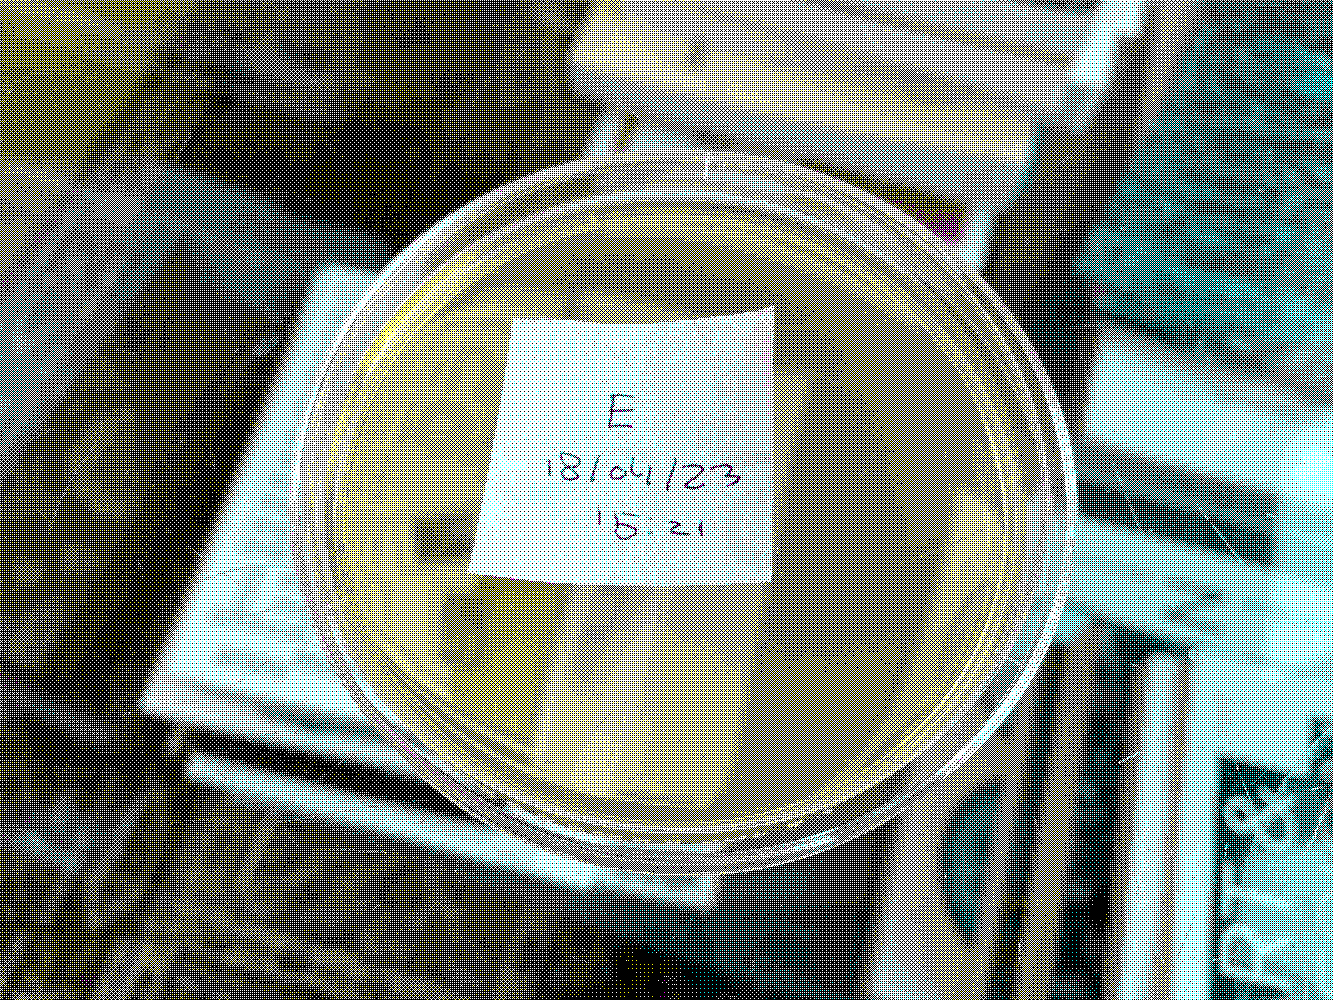
Petri-Typografie
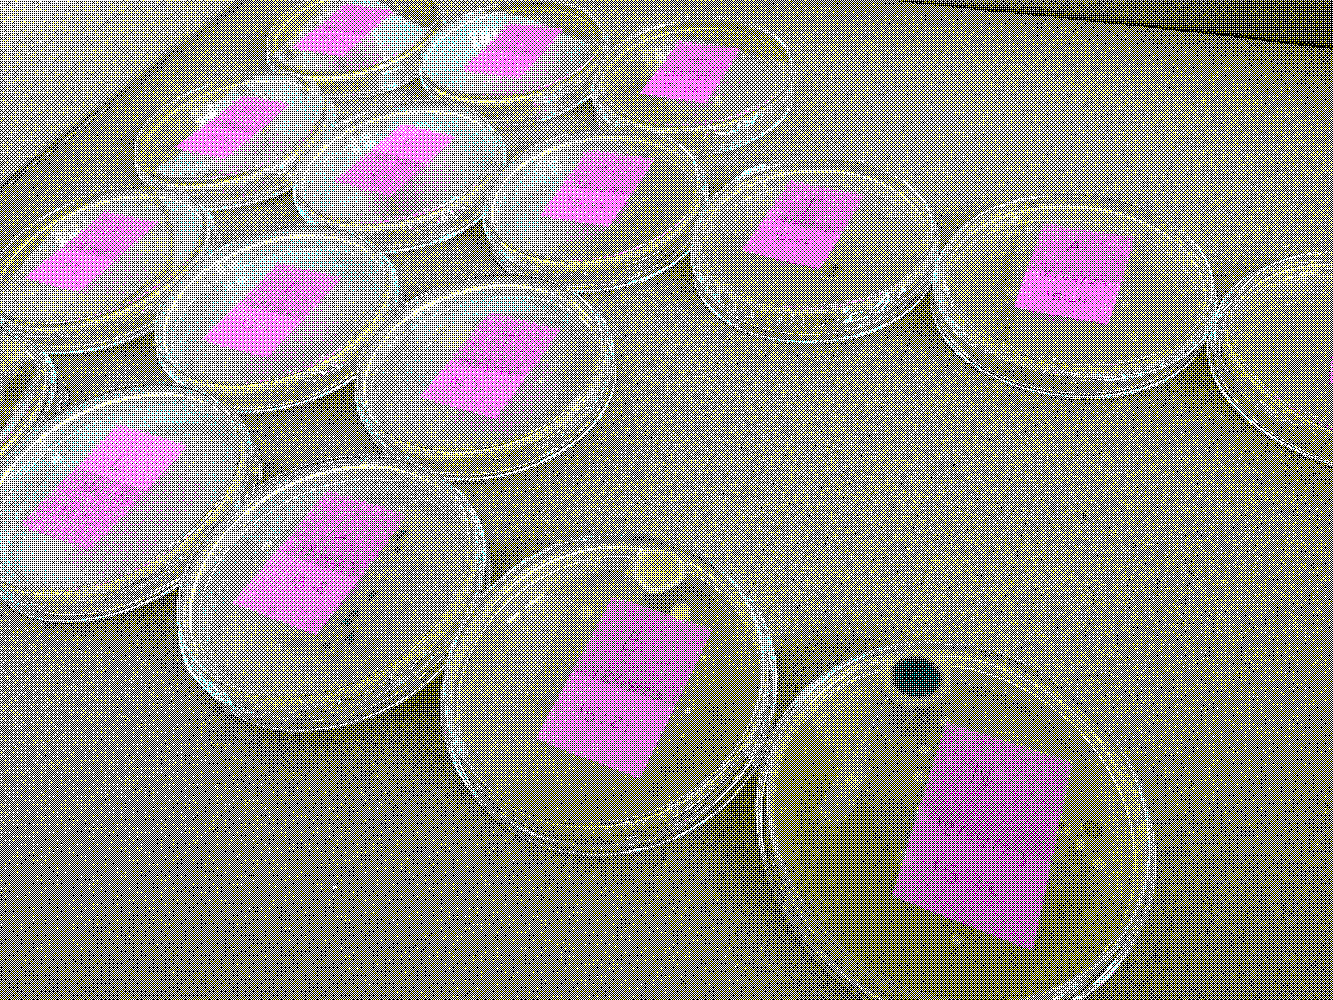
Petri-Typografie
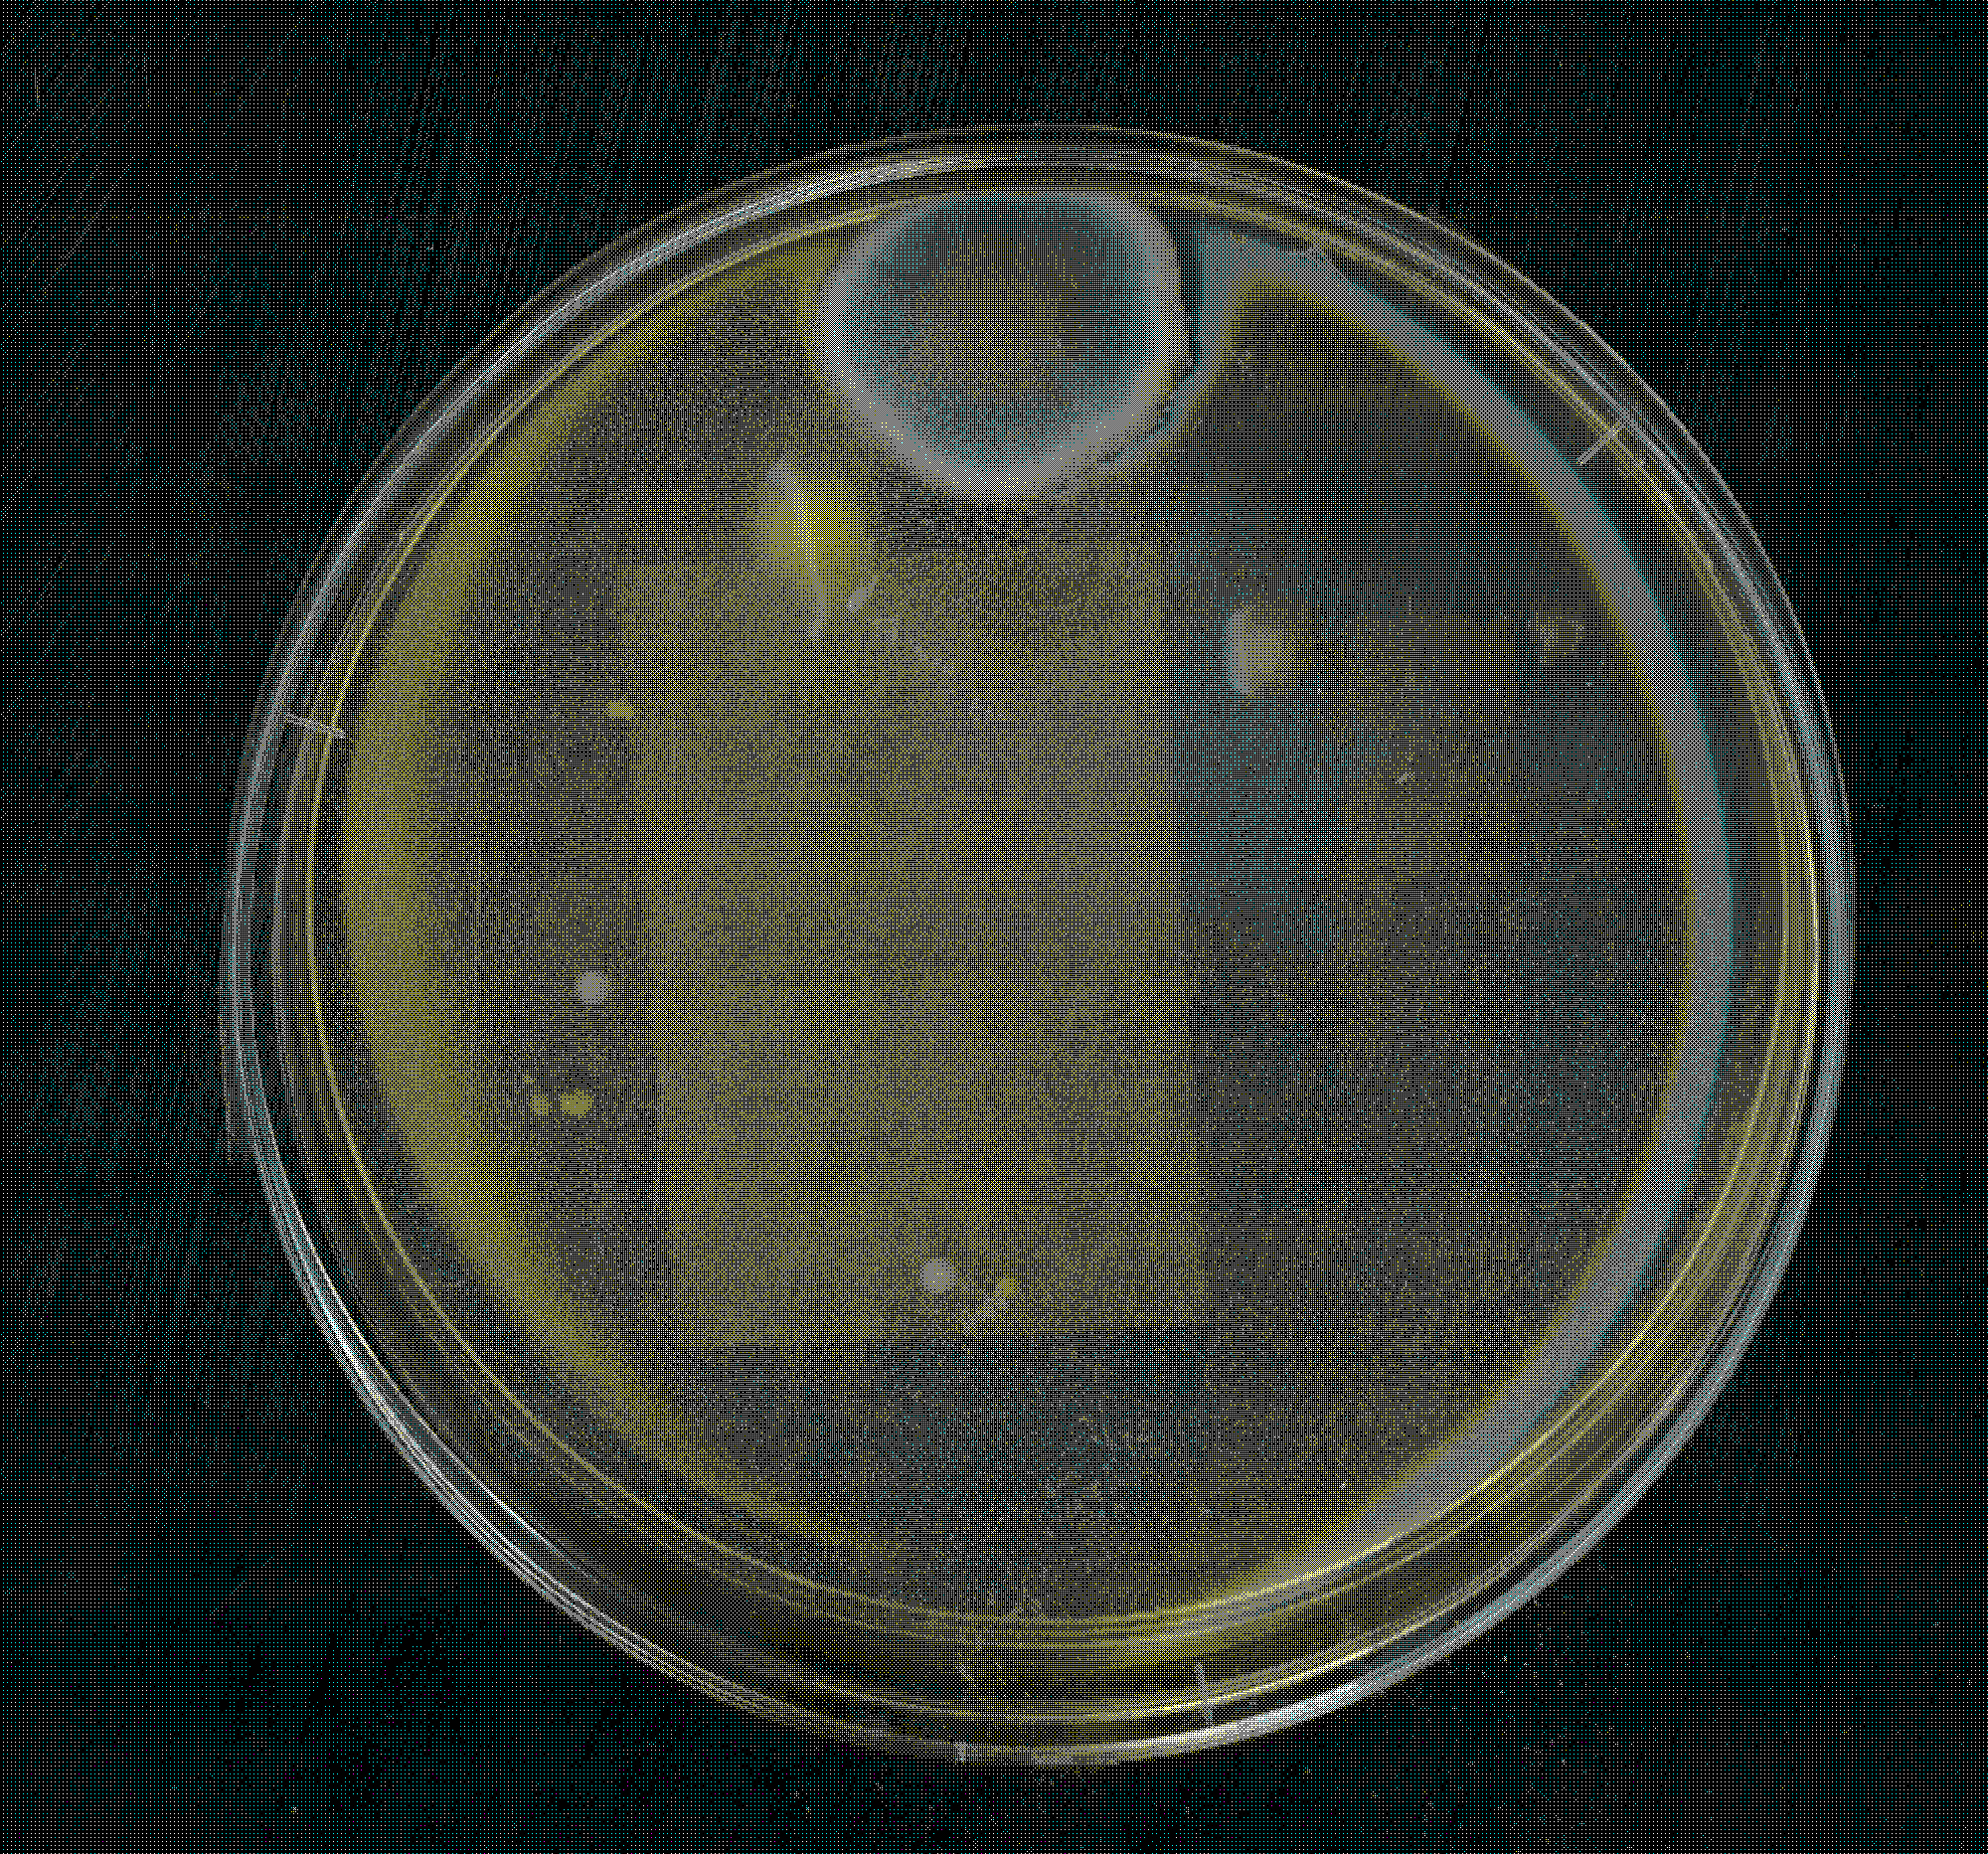
Petri-Typografie
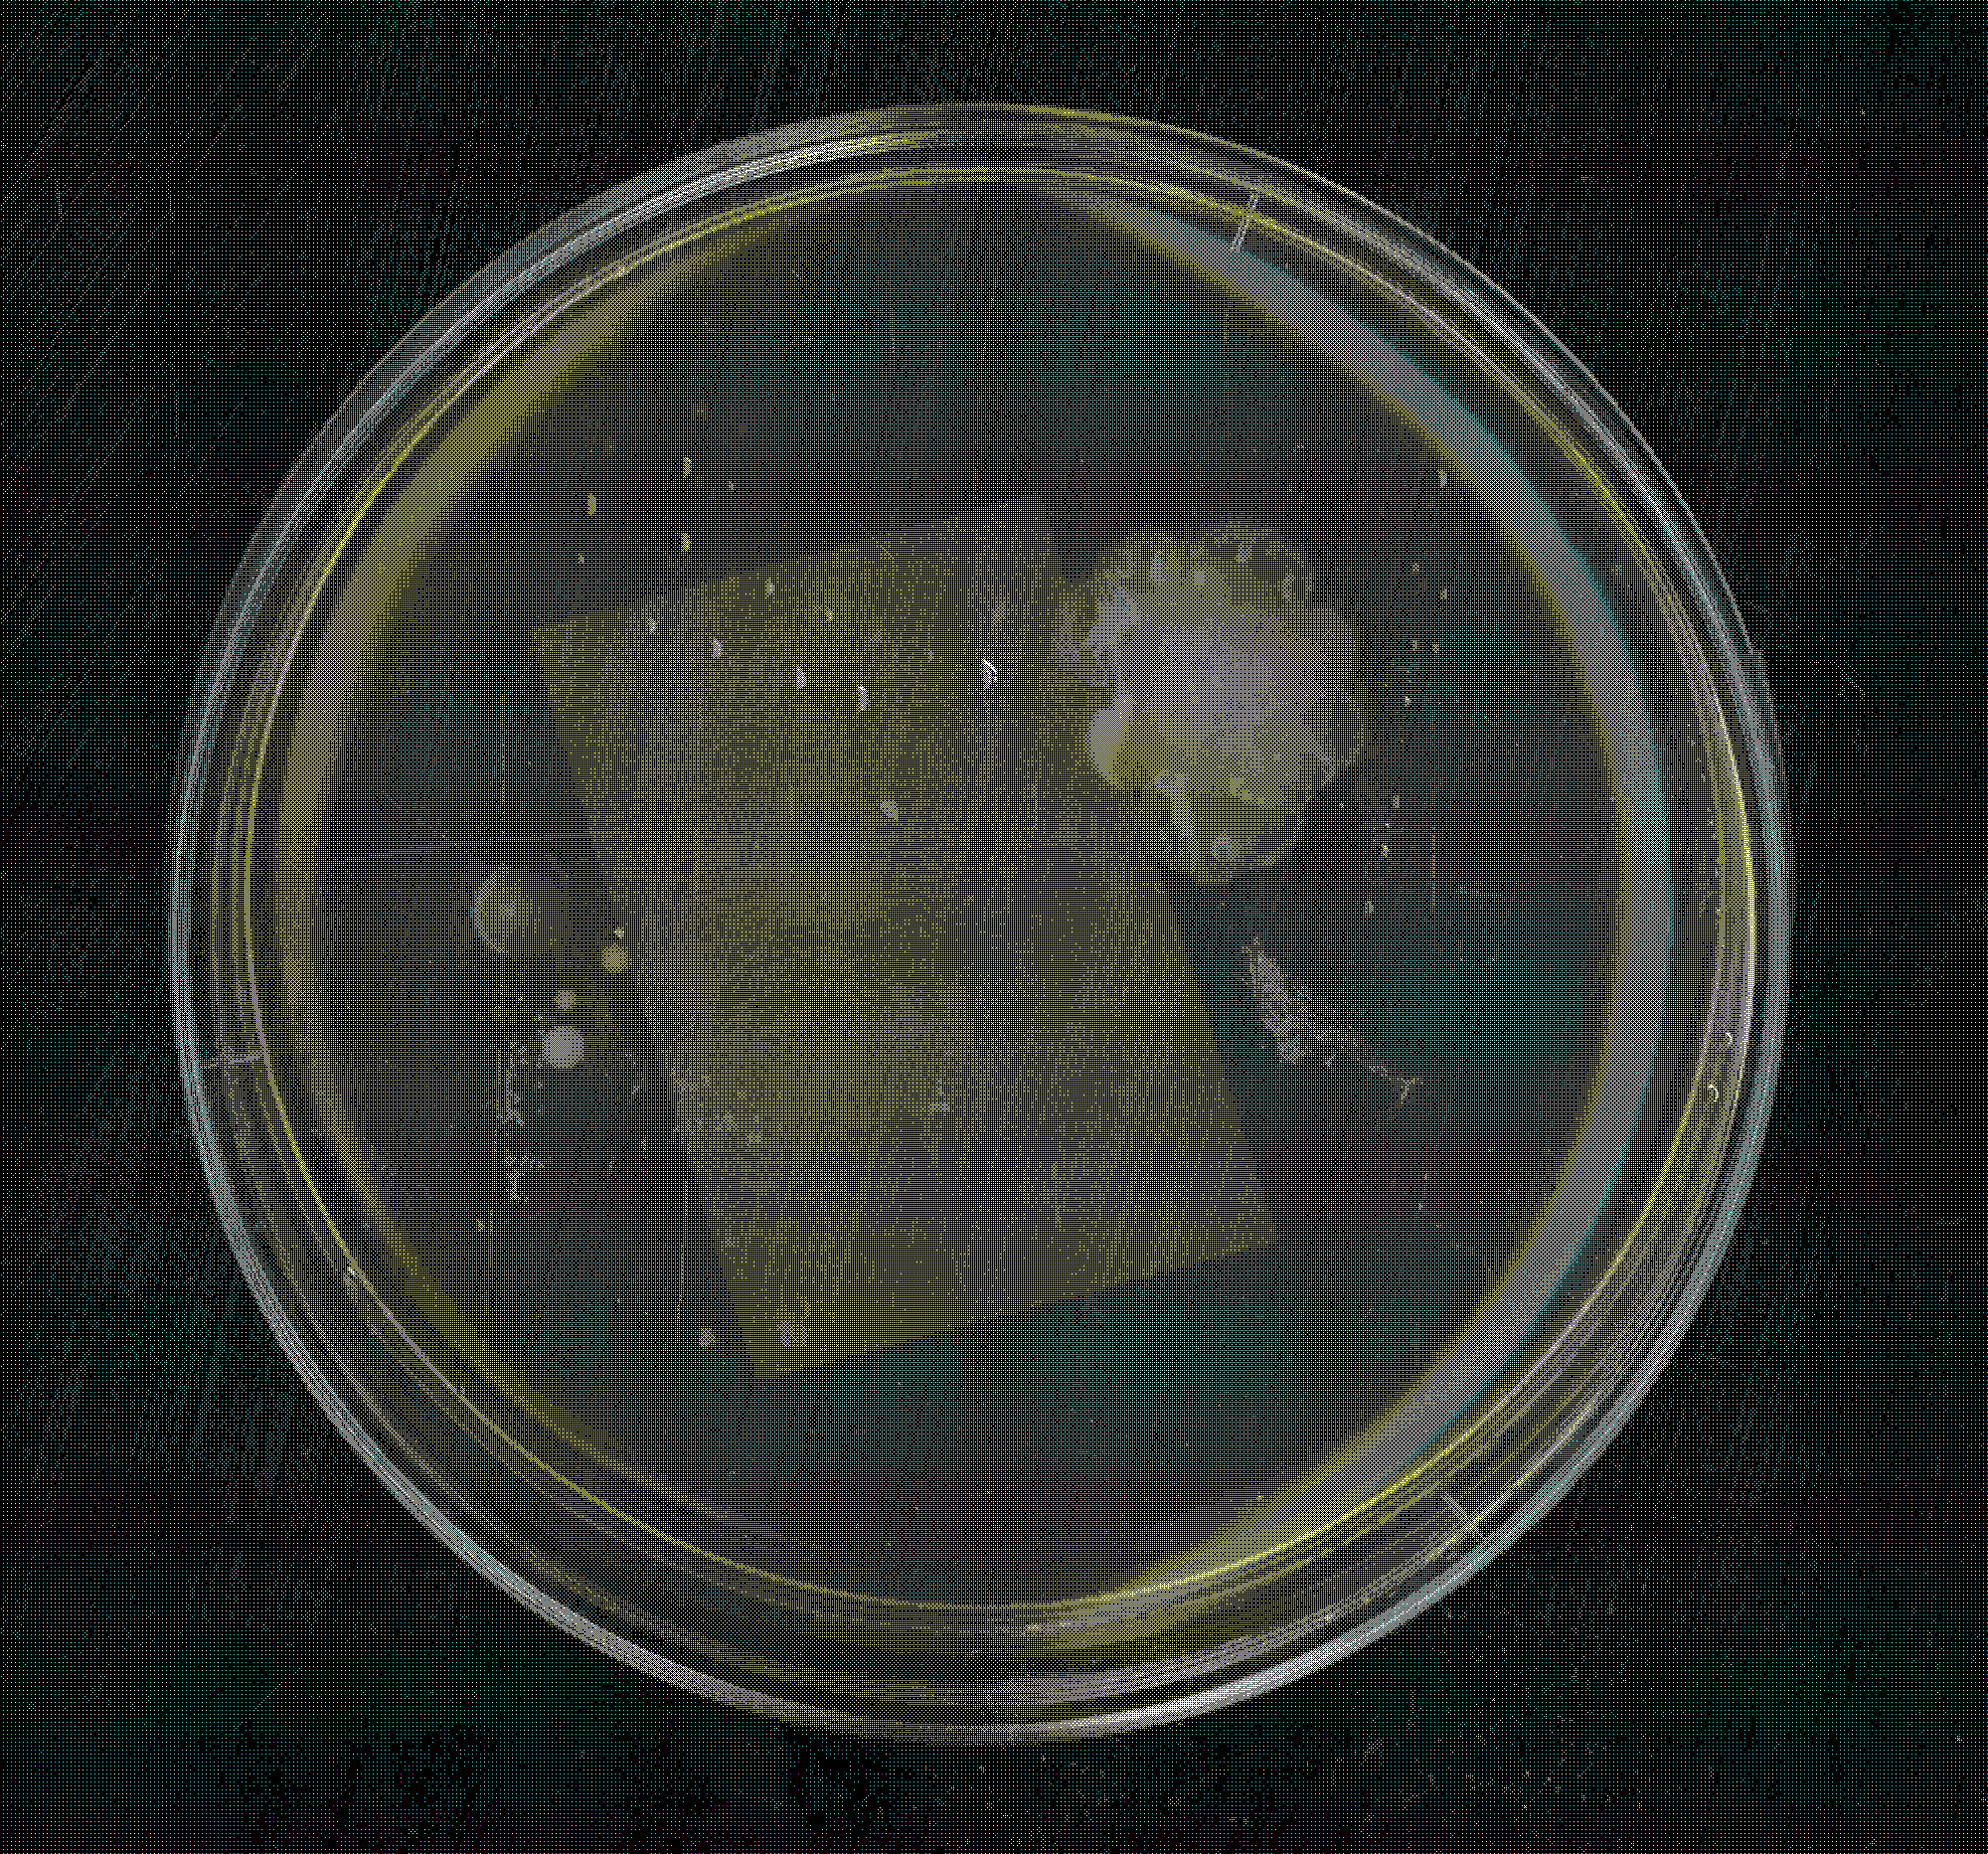
Petri-Typografie
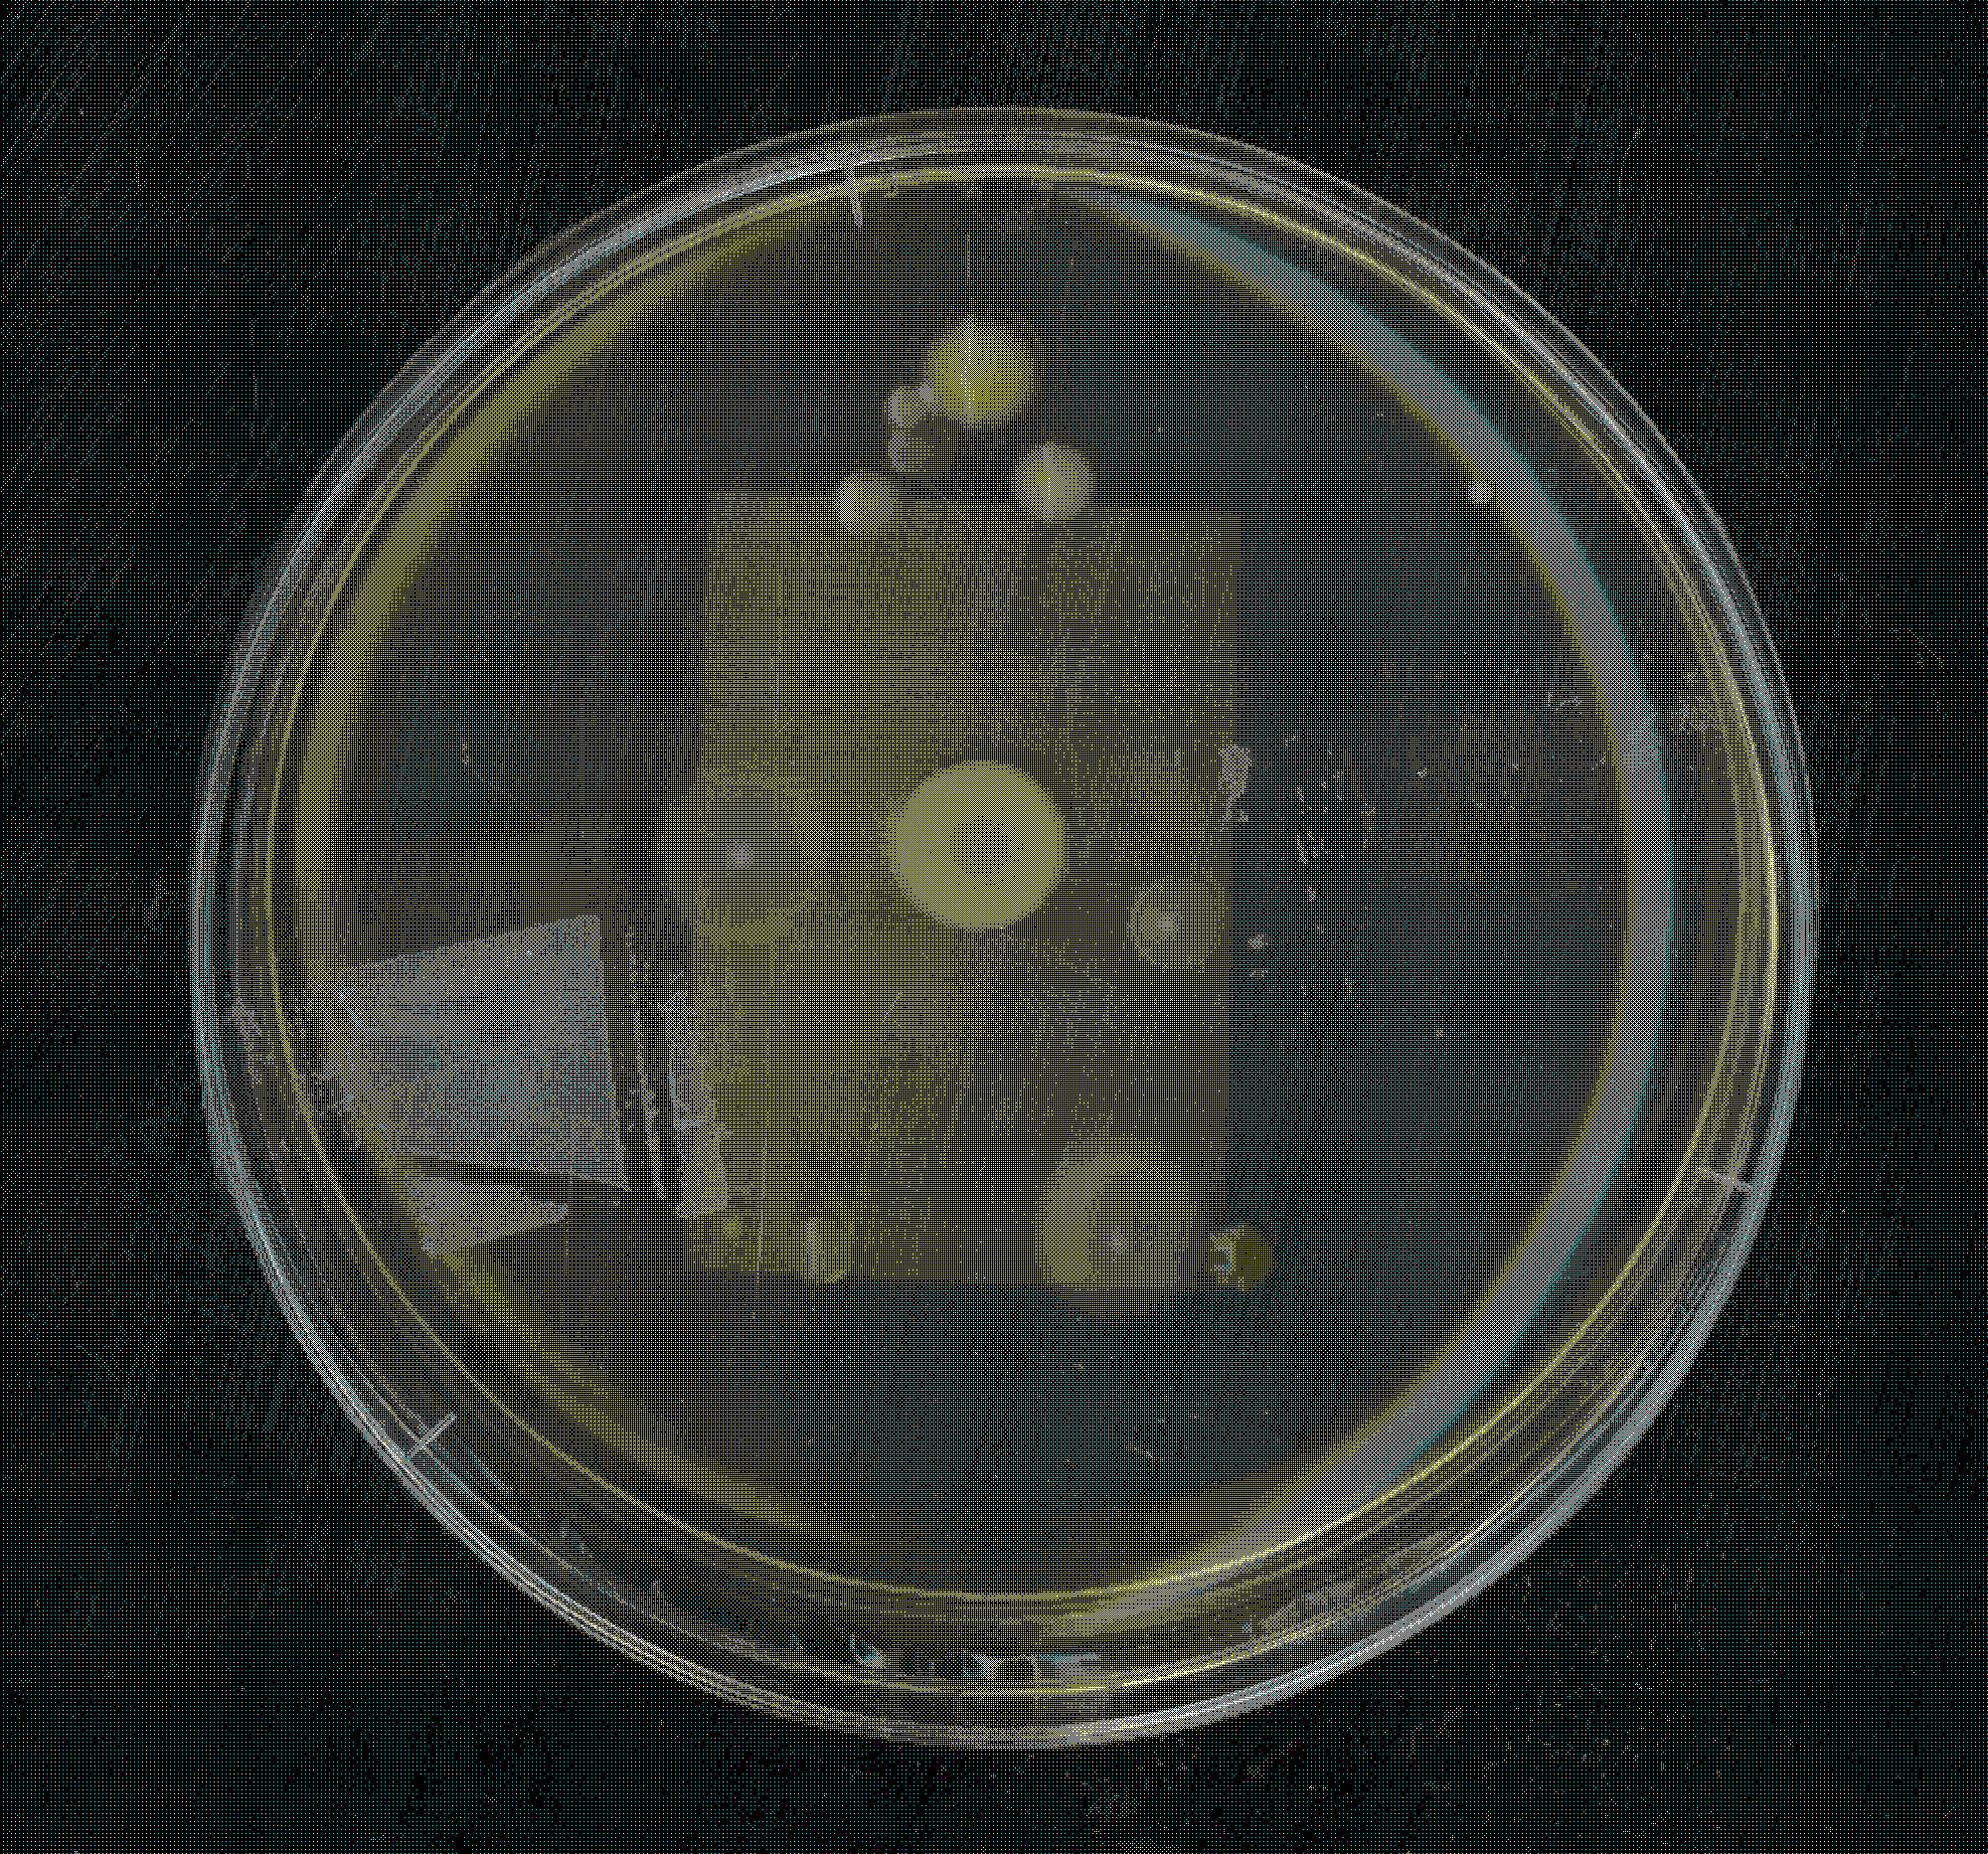
Petri-Typografie
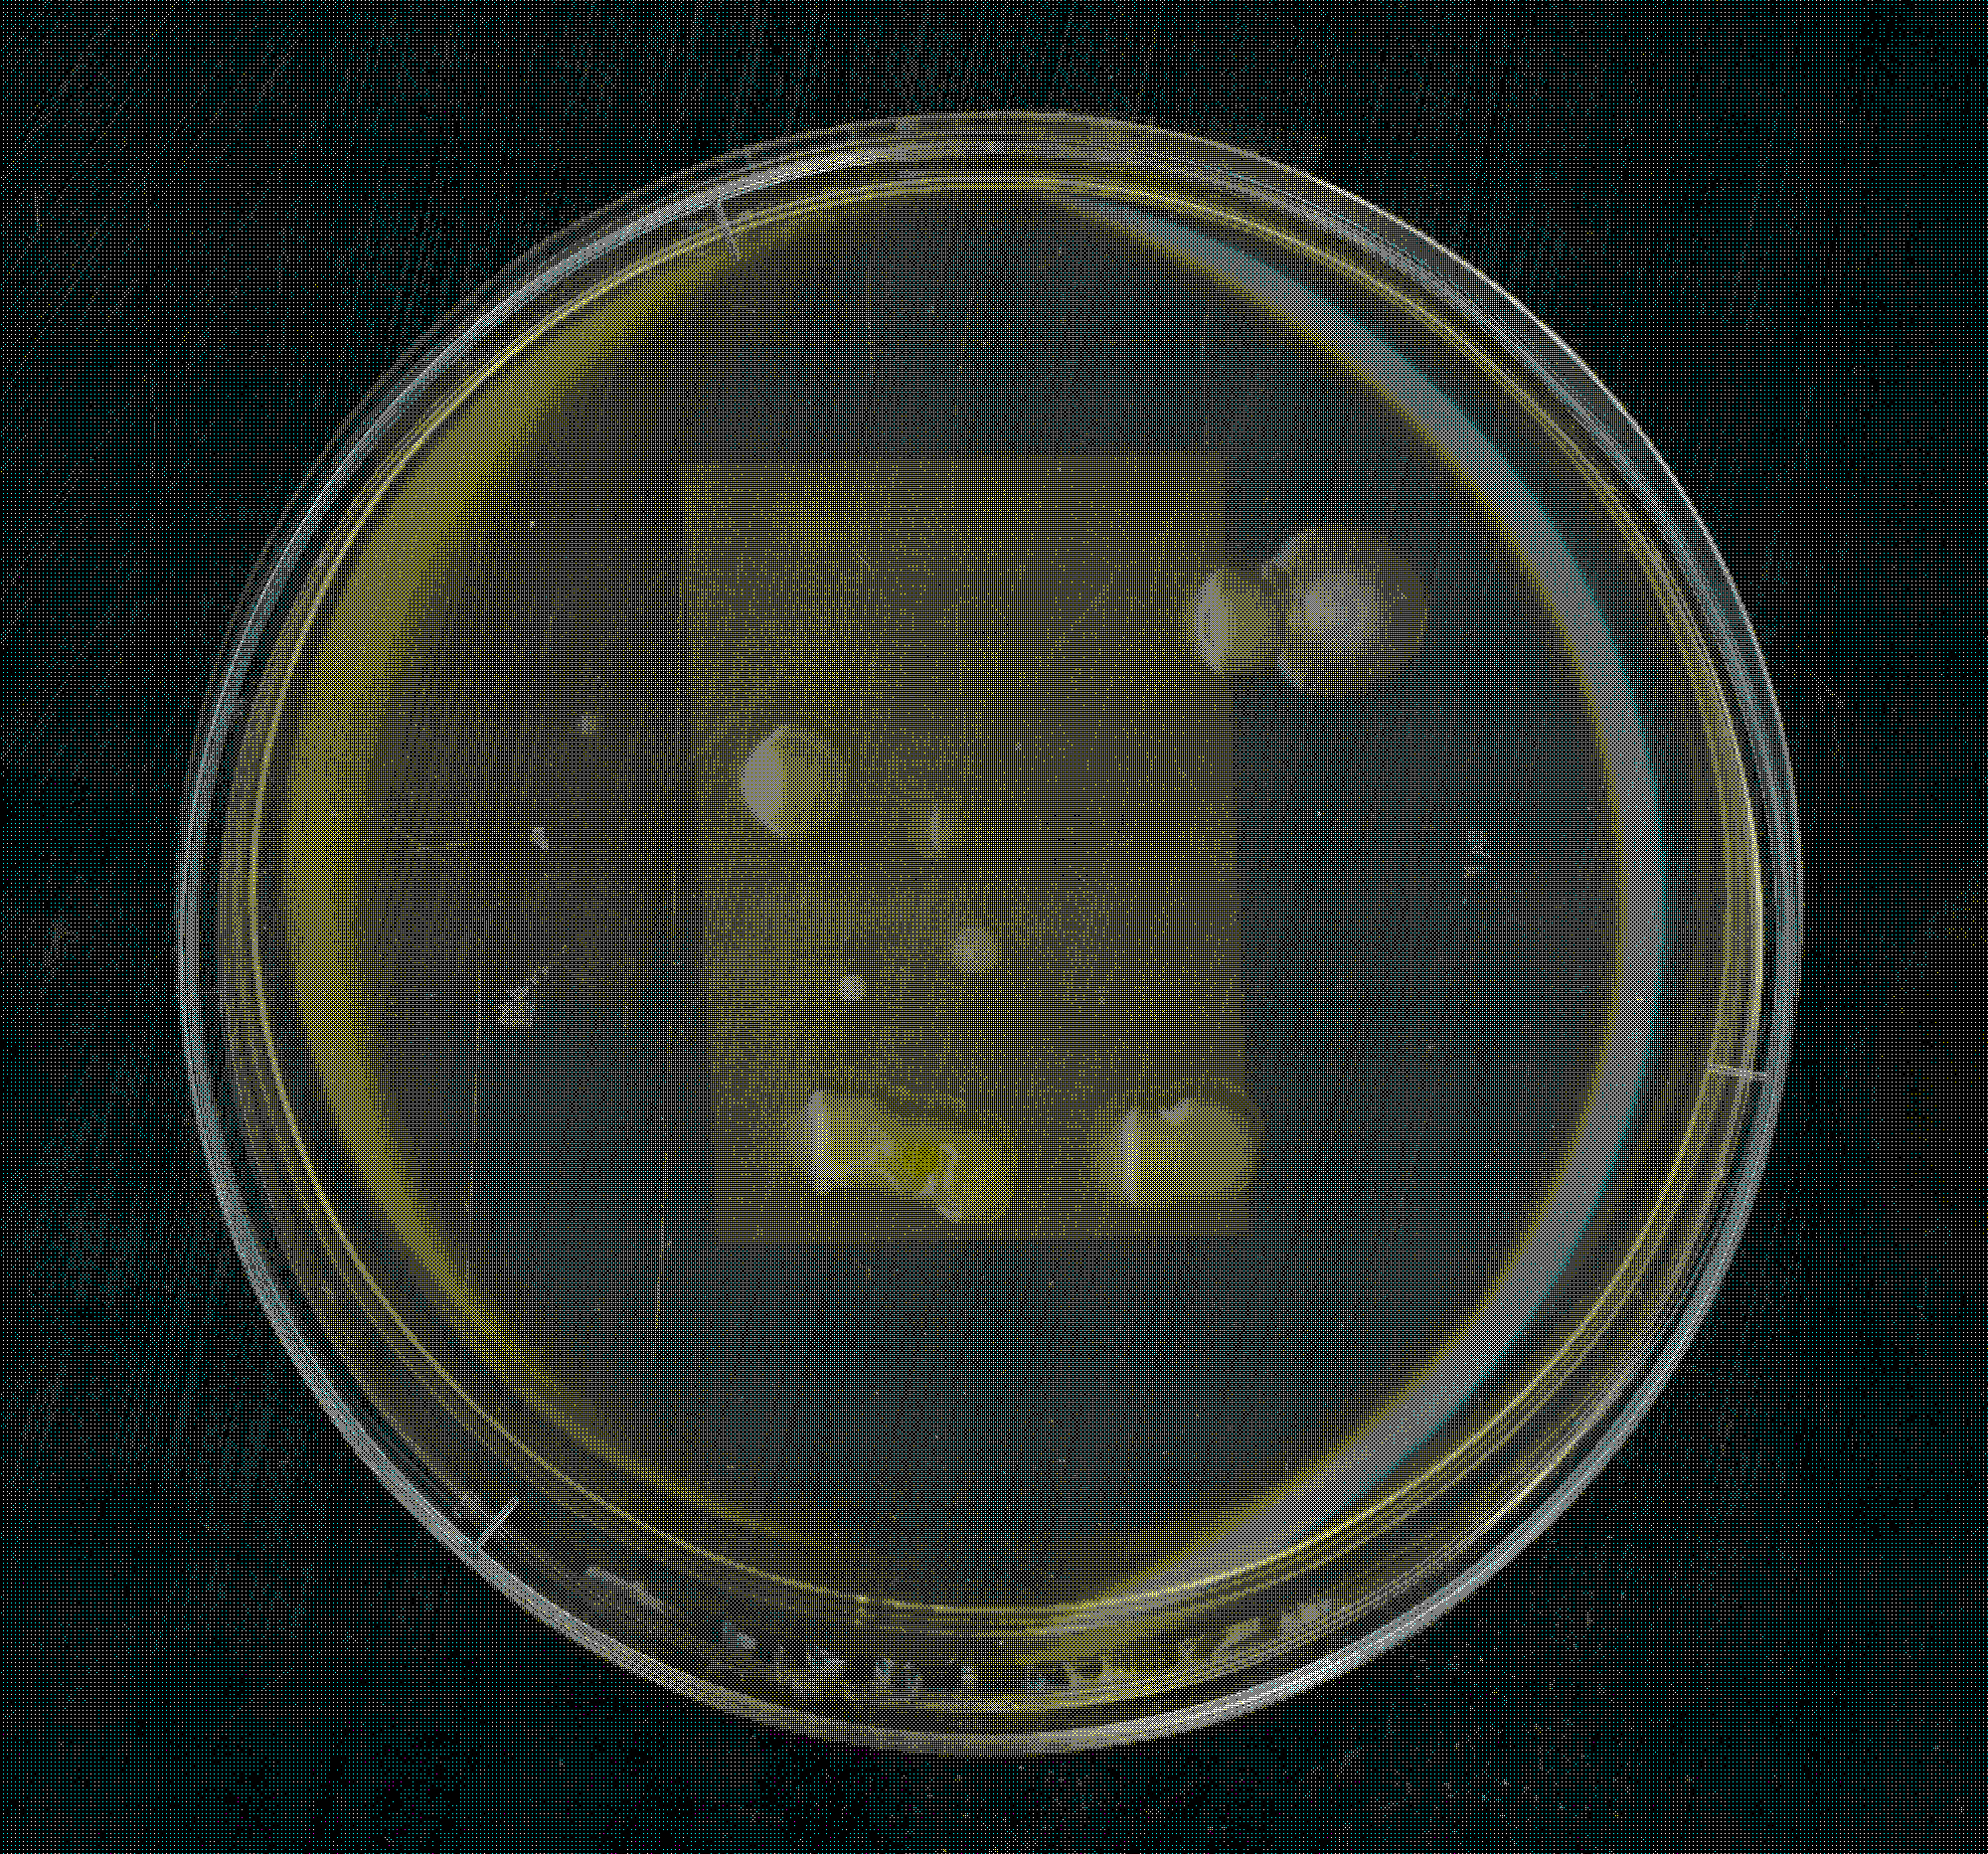
Petri-Typografie
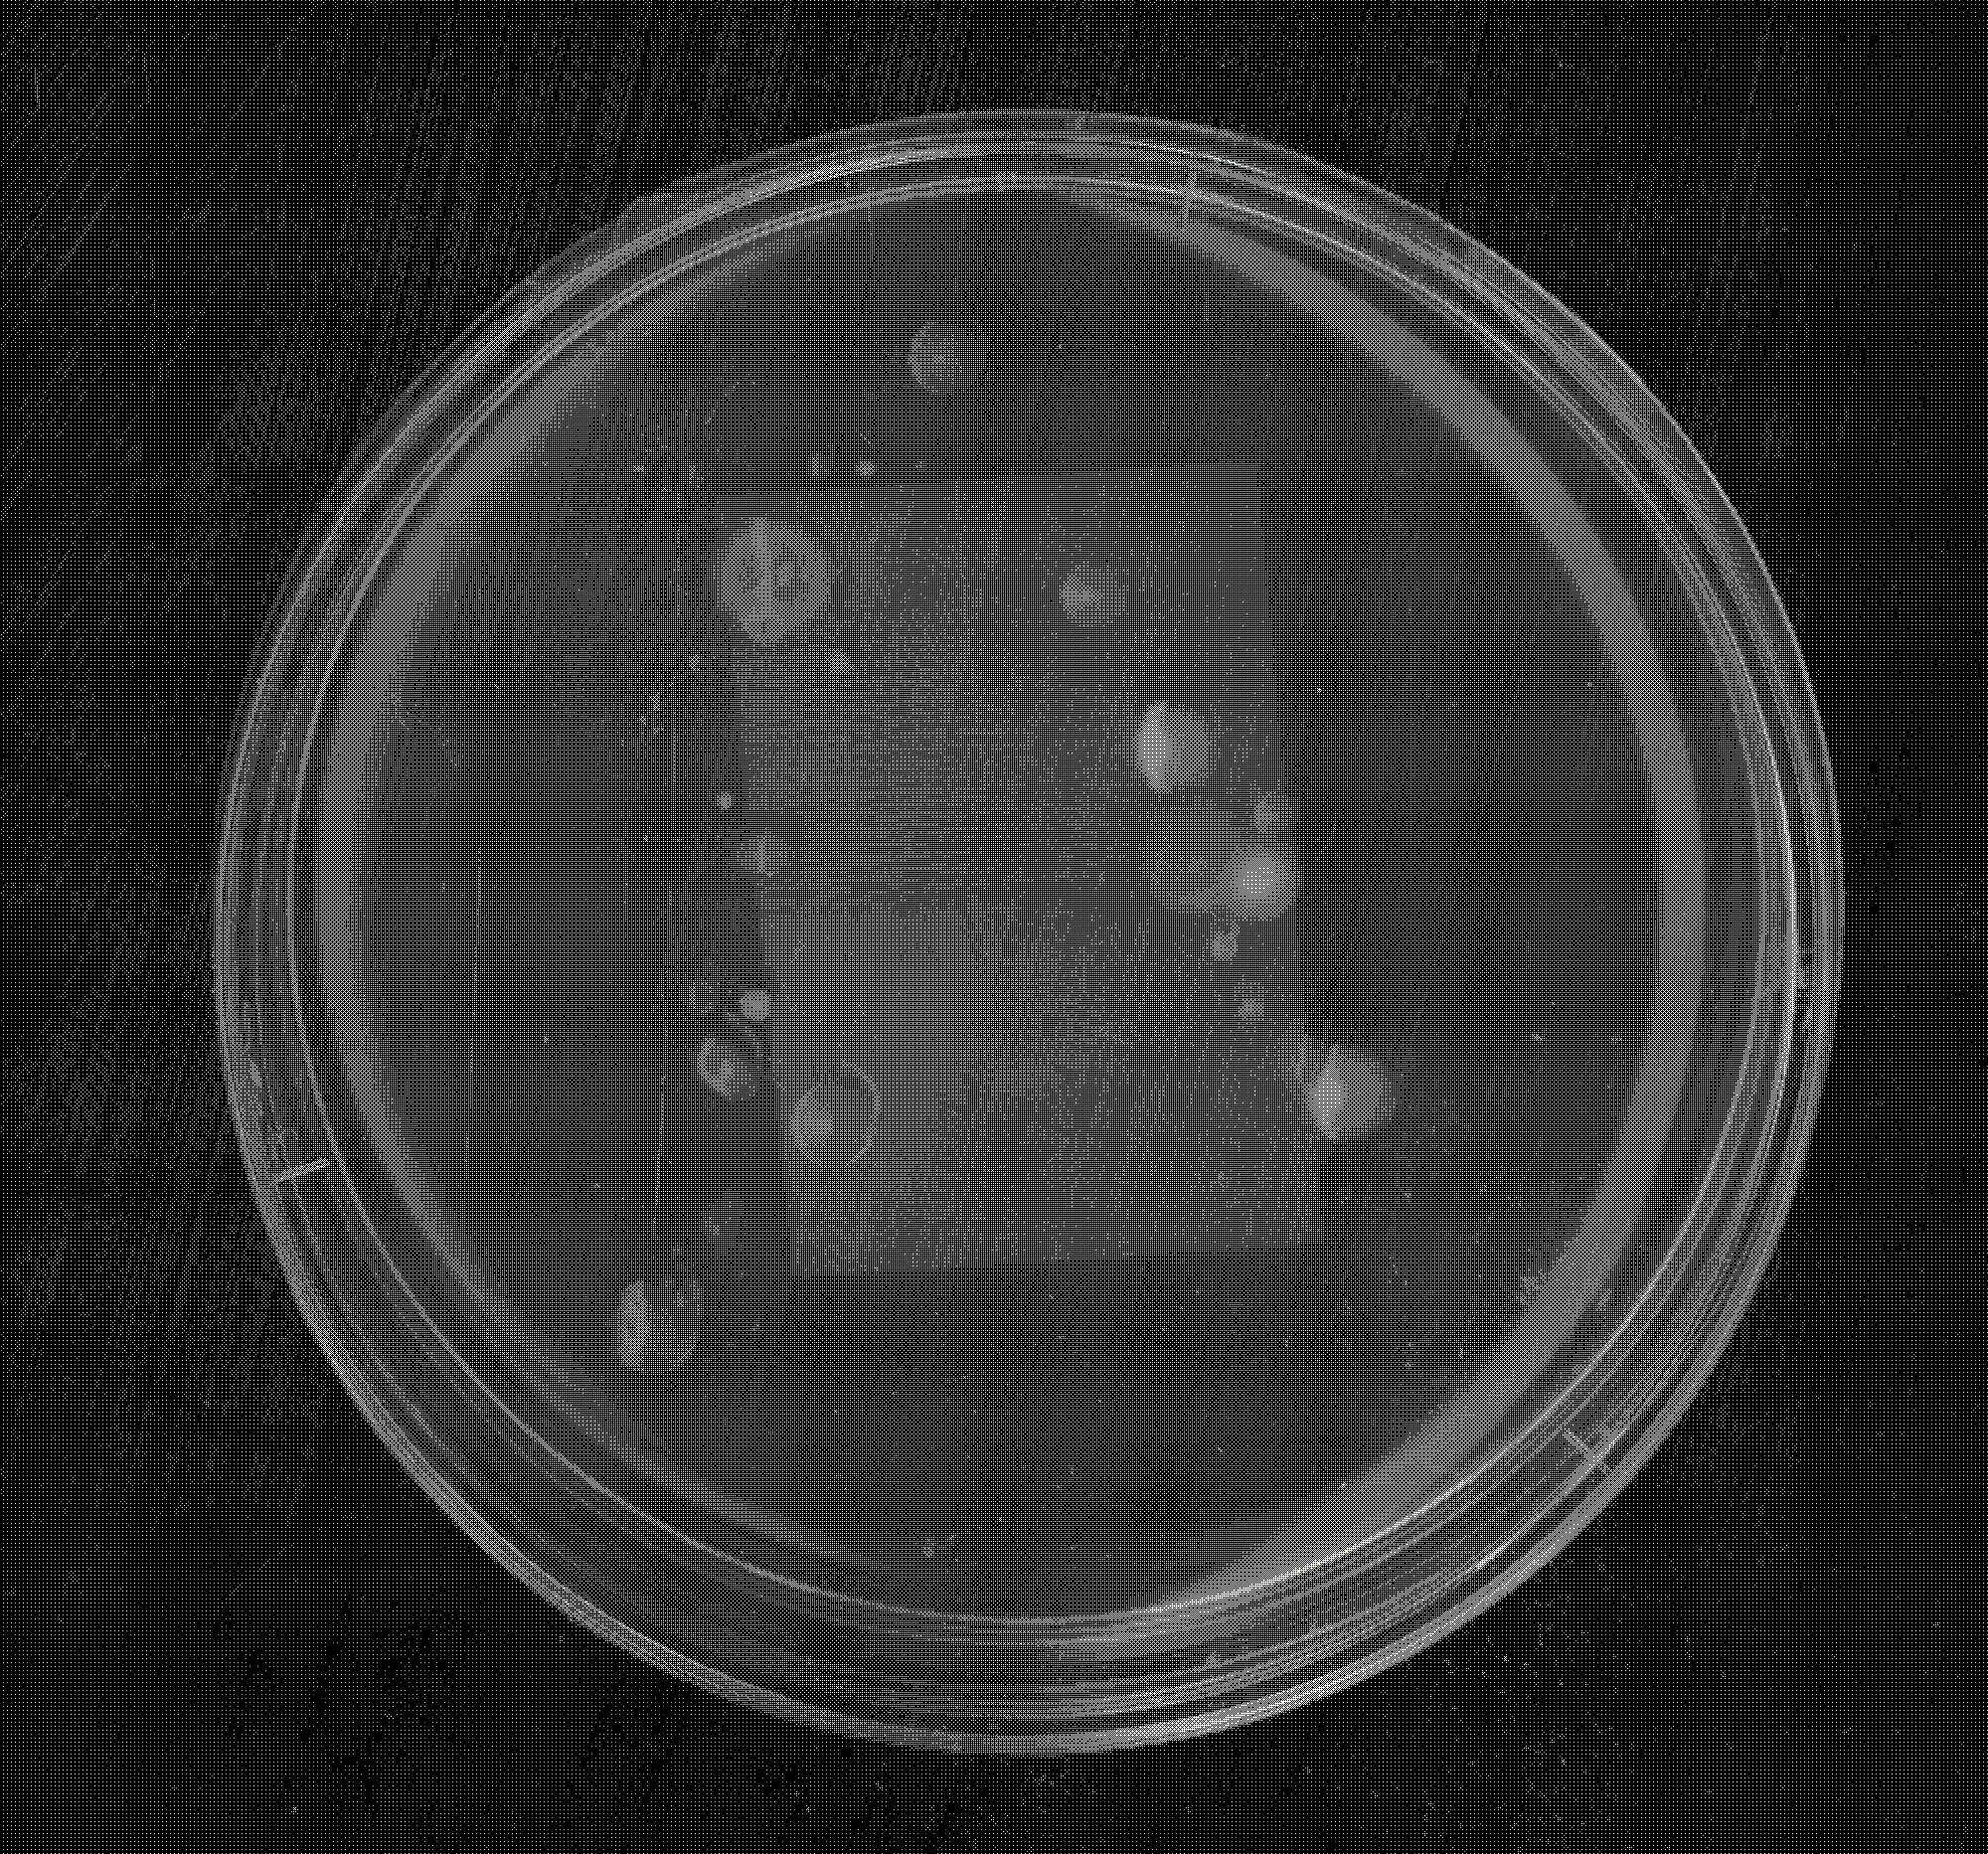
Petri-Typografie
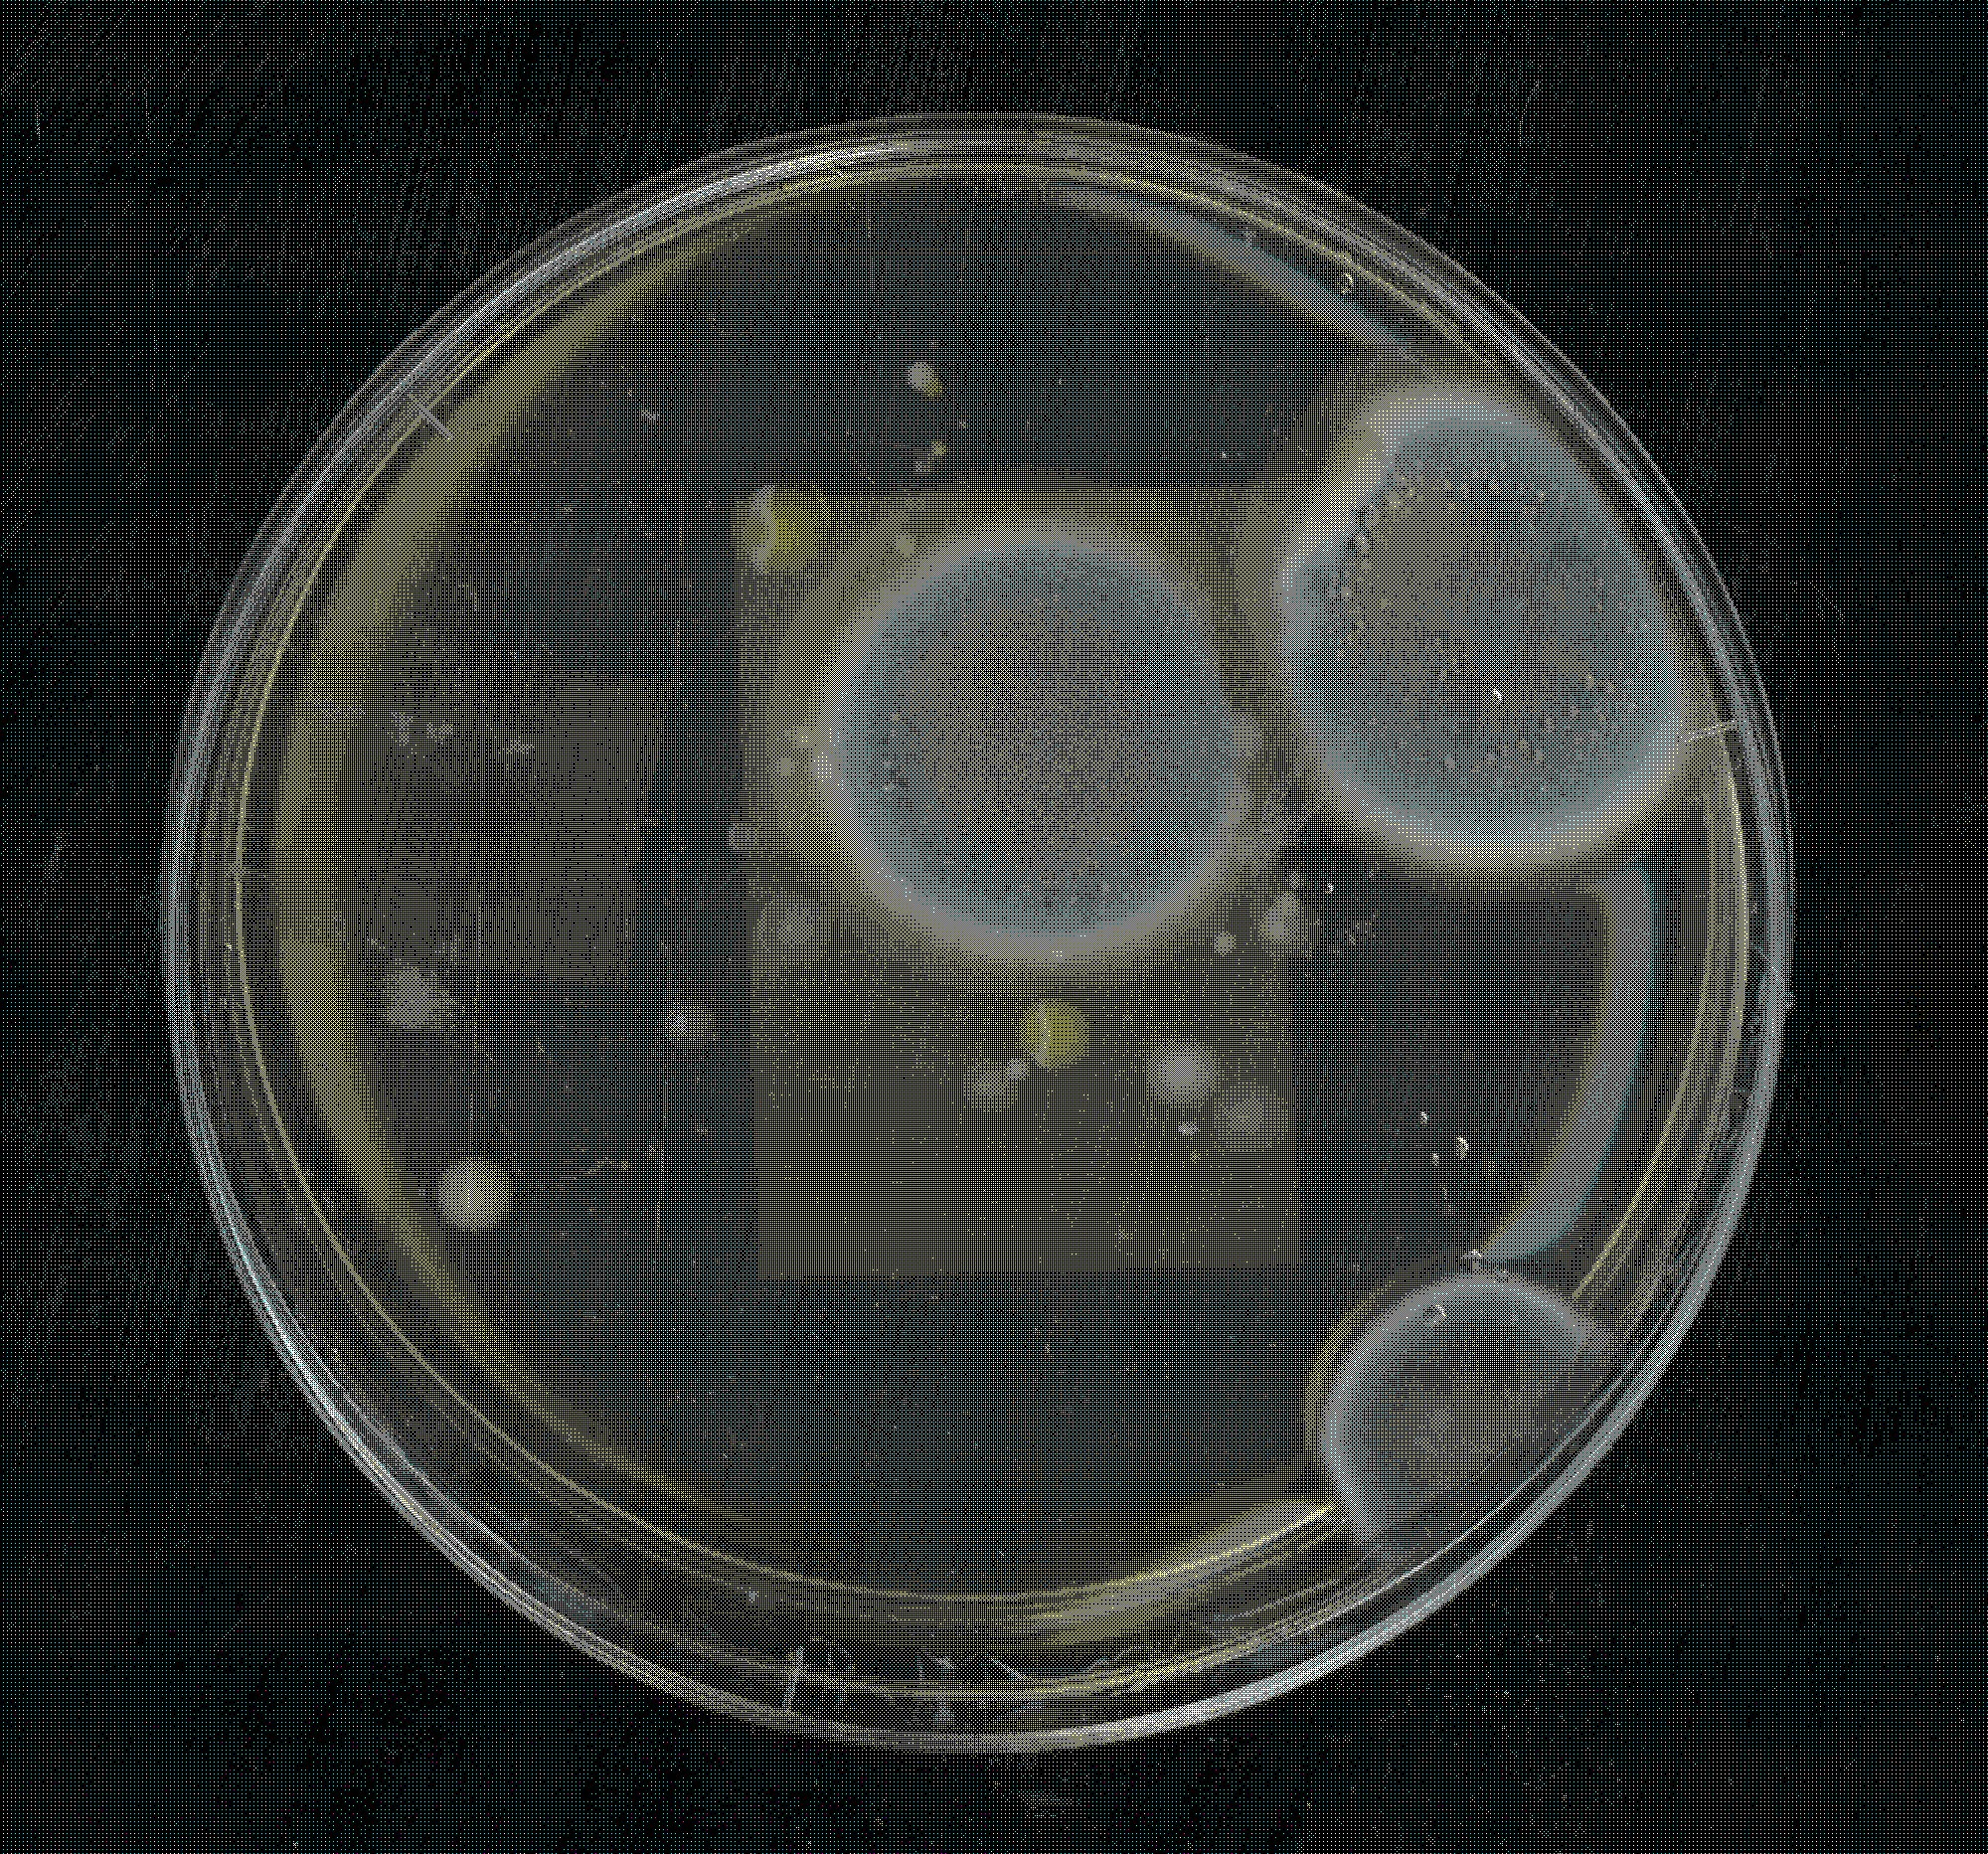
Petri-Typografie
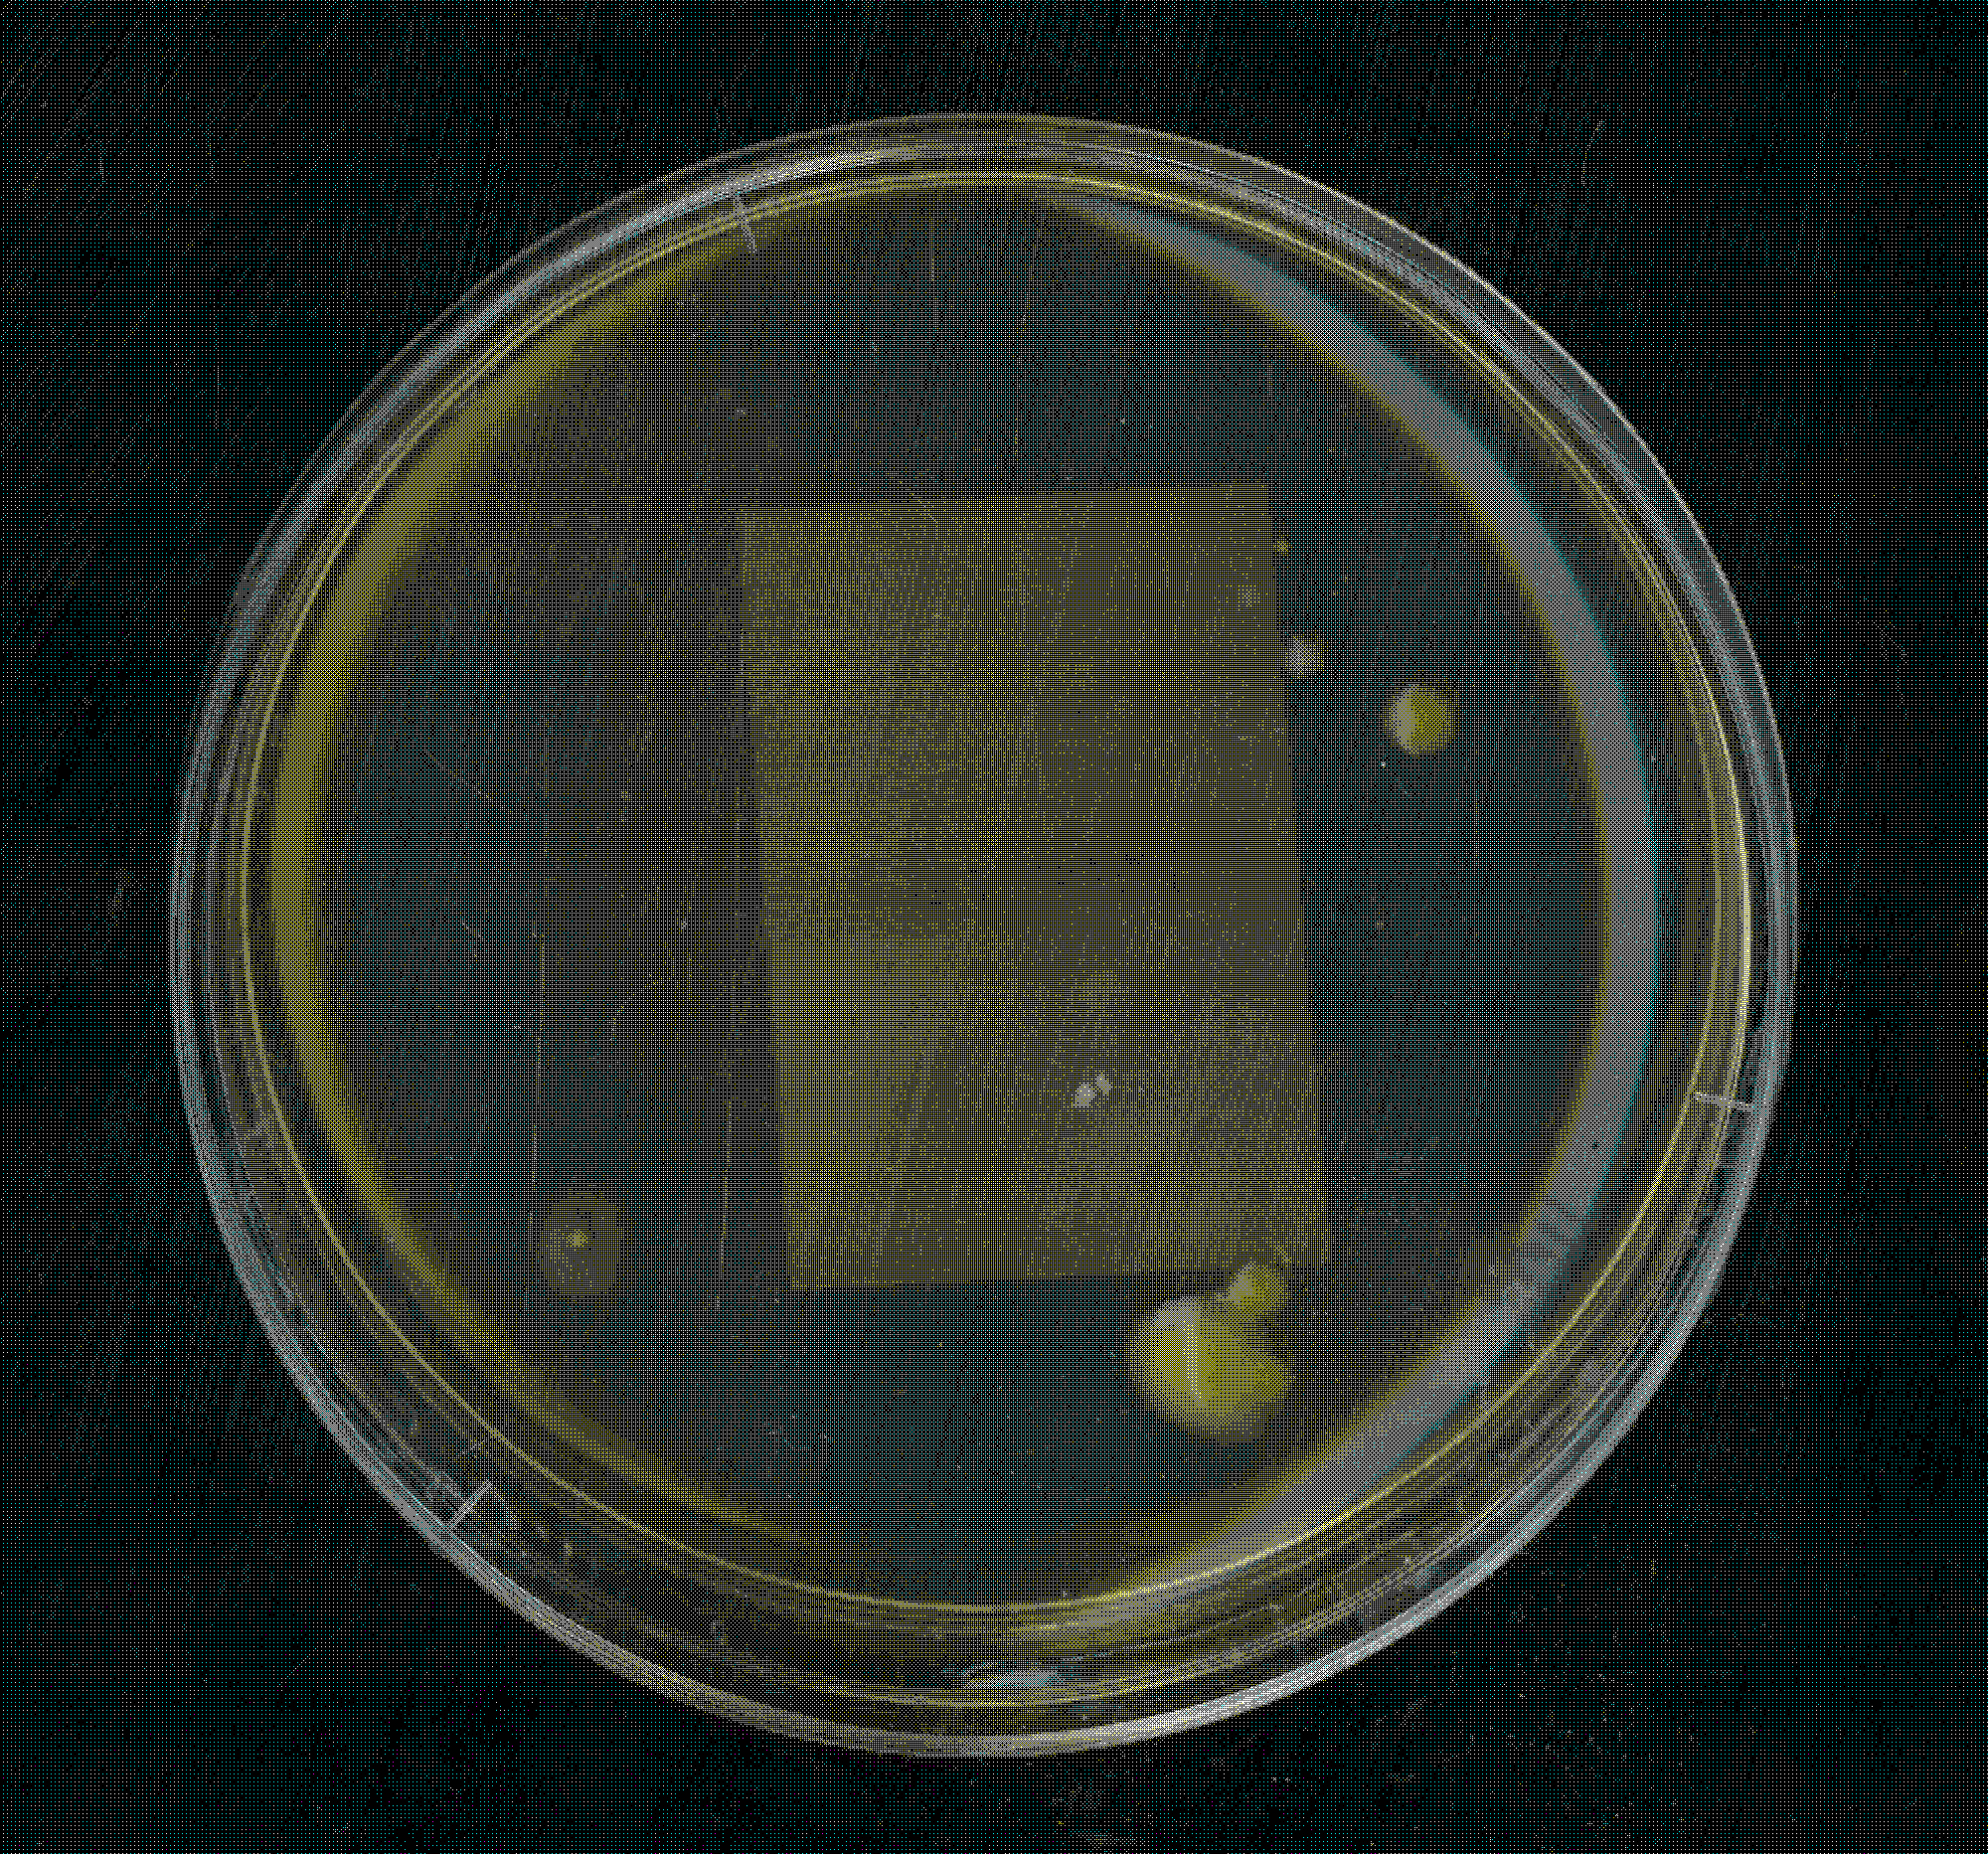
Petri-Typografie
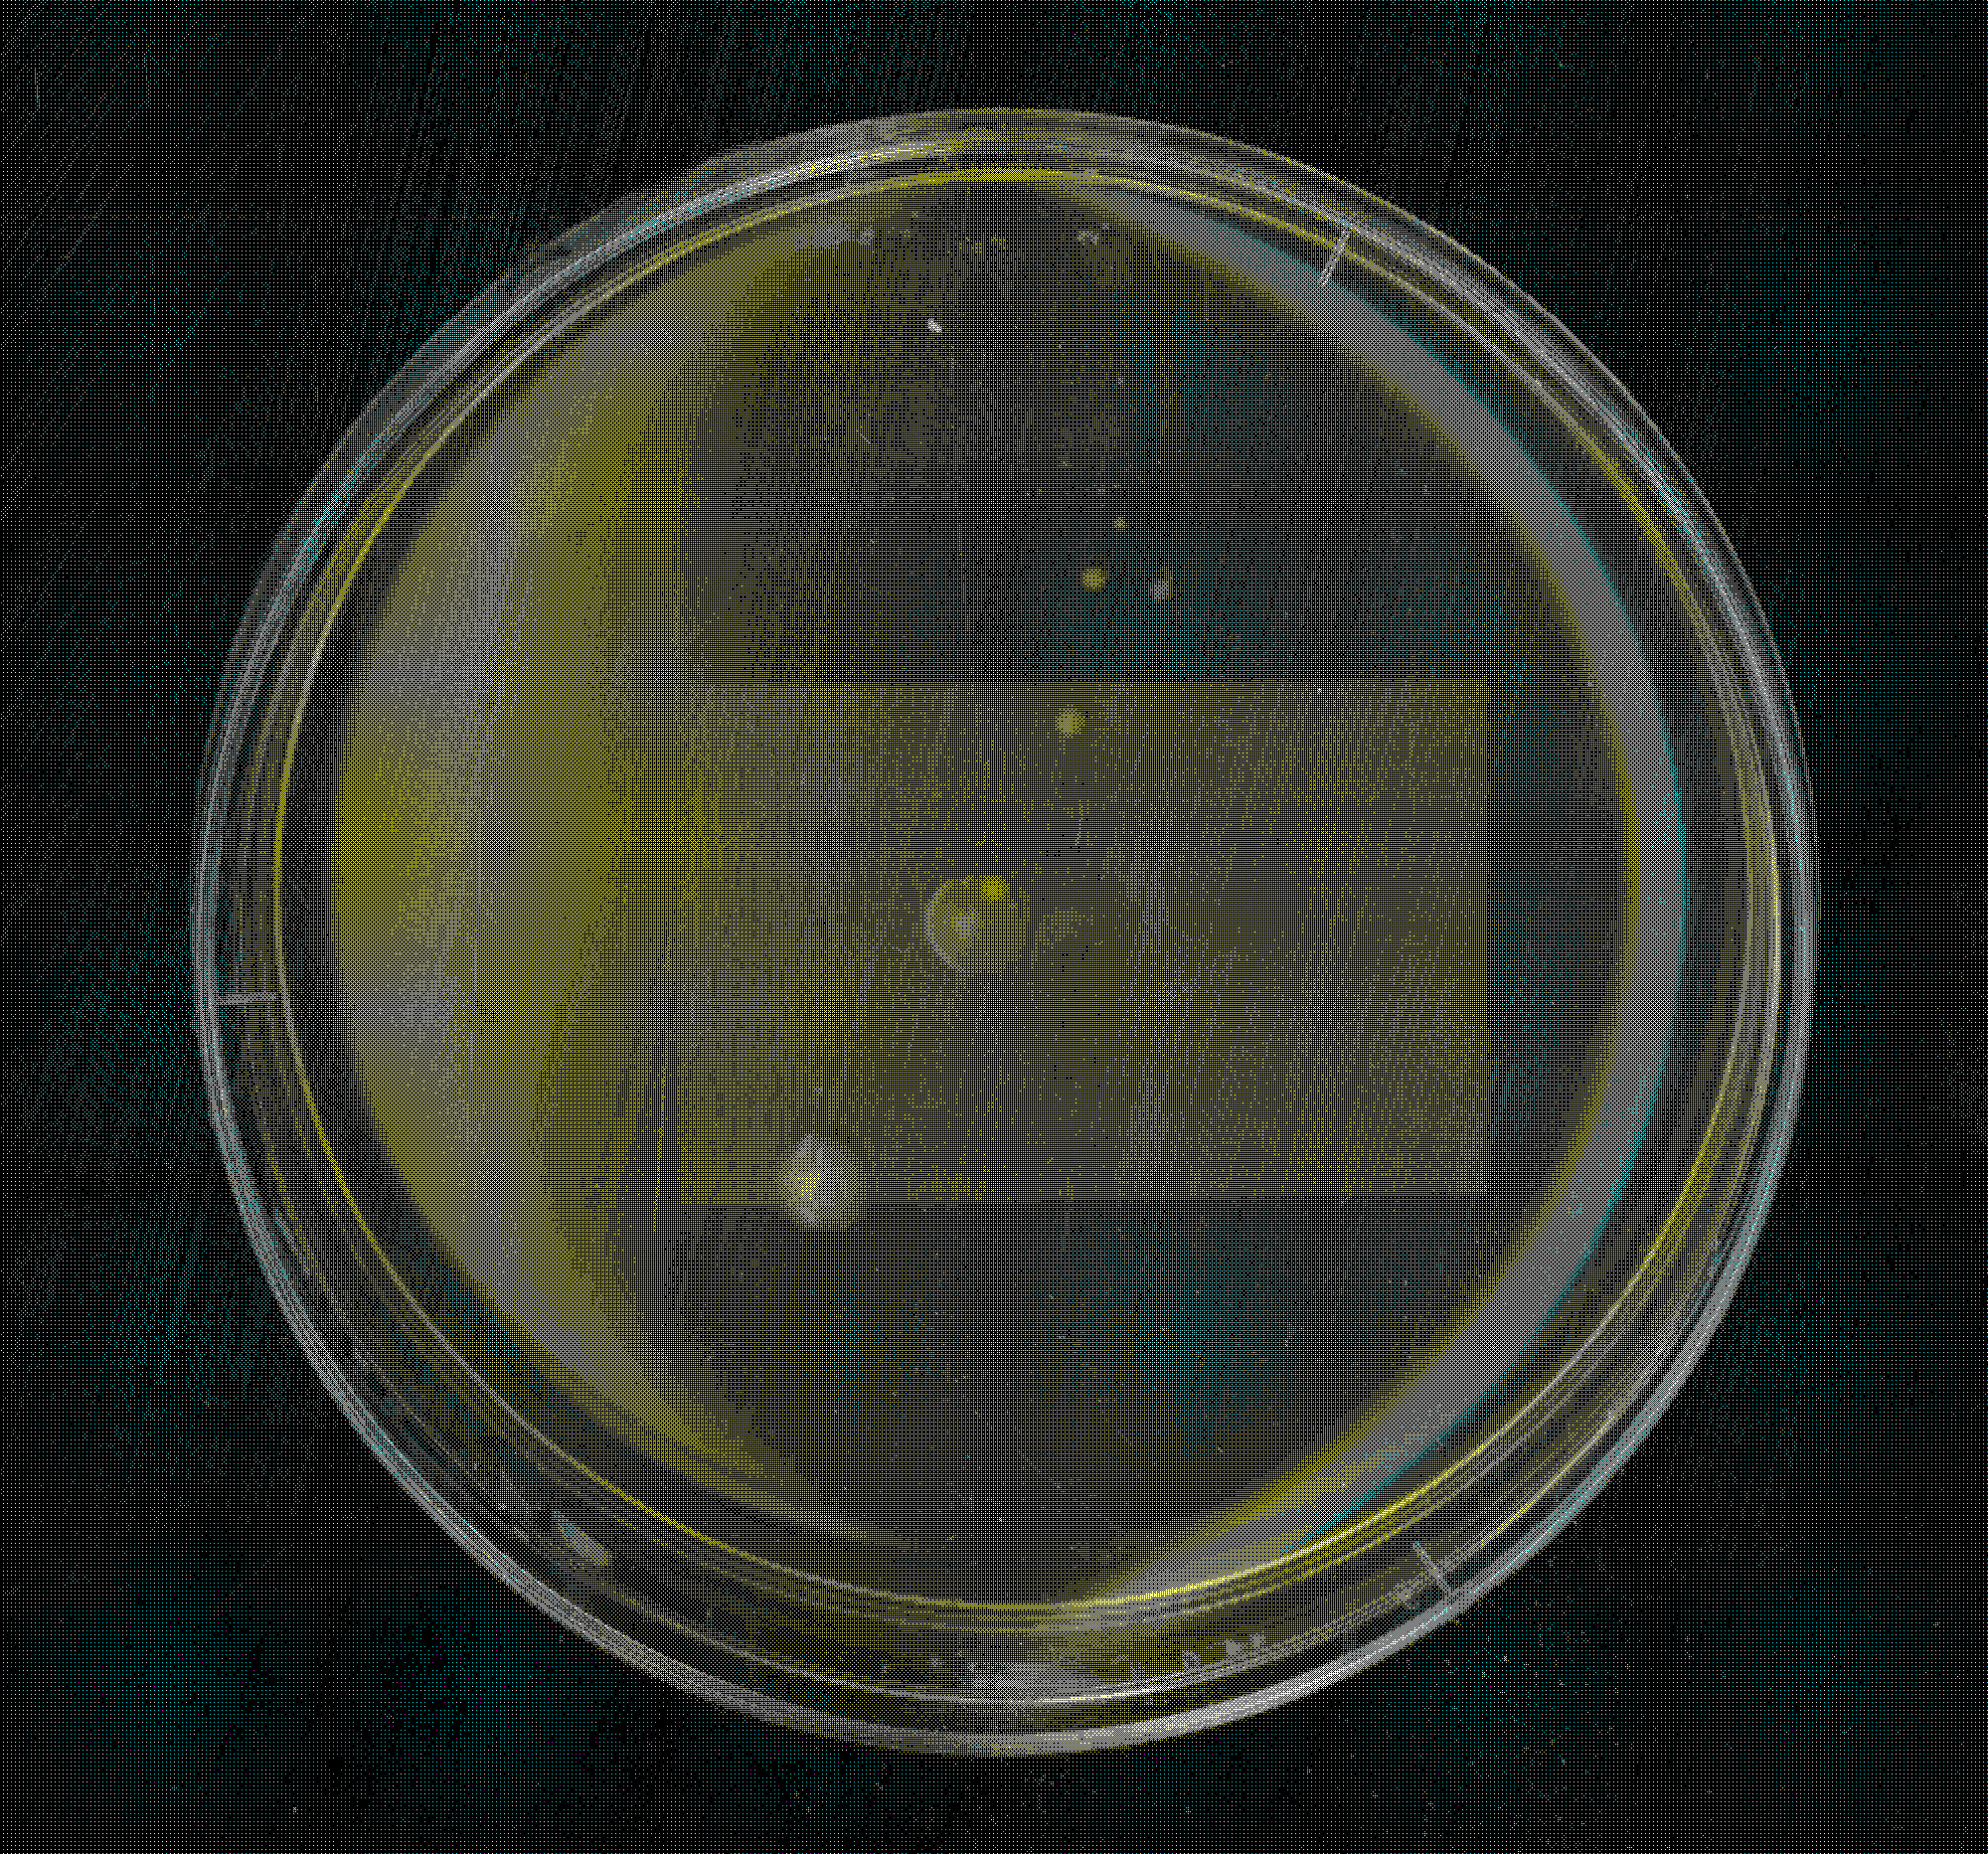
Petri-Typografie
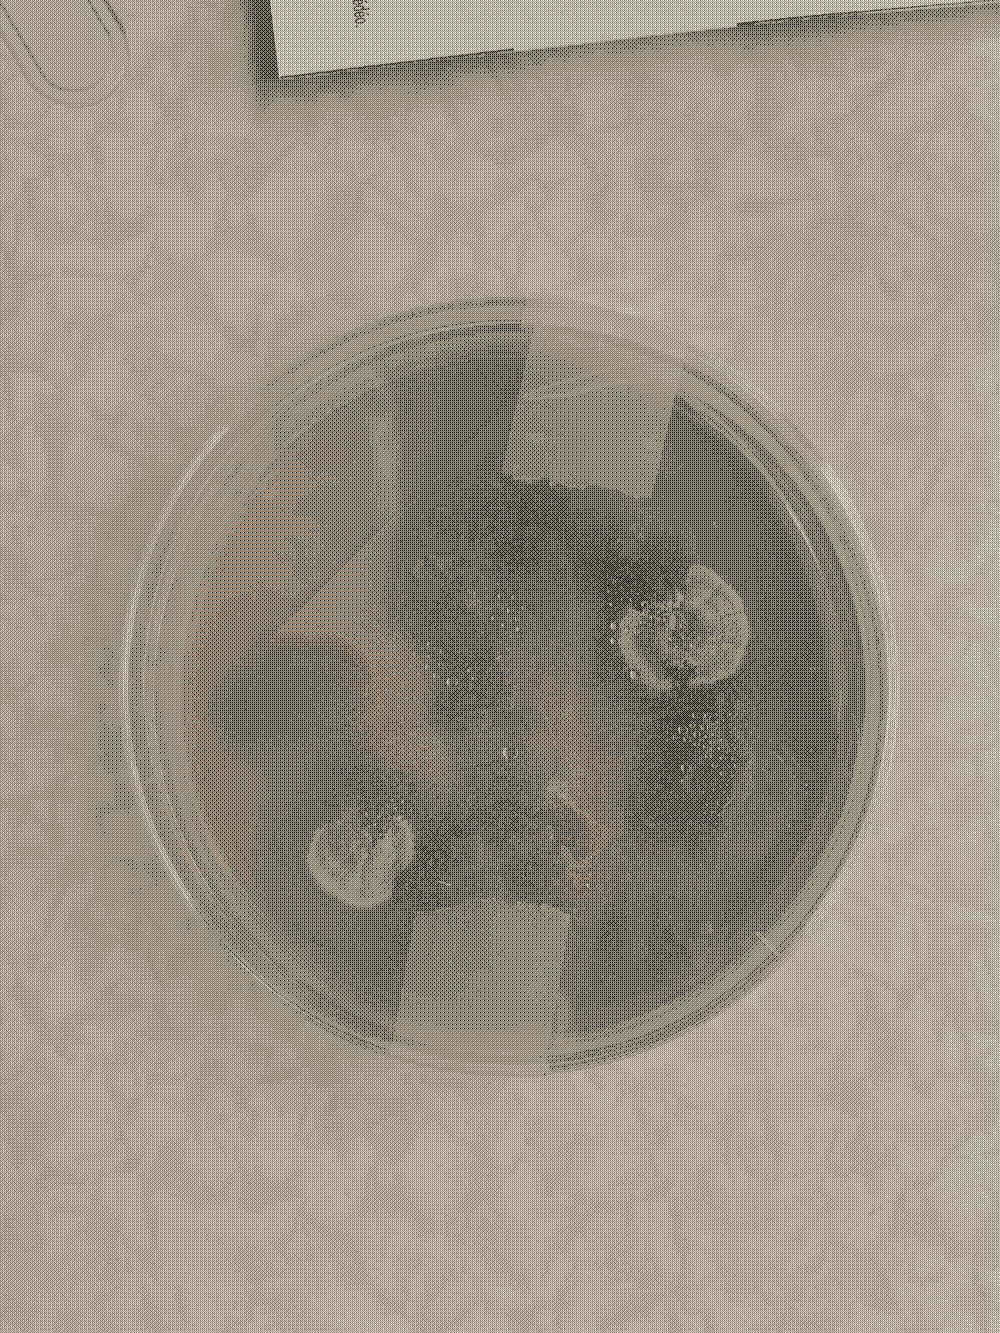
Petri-Typografie
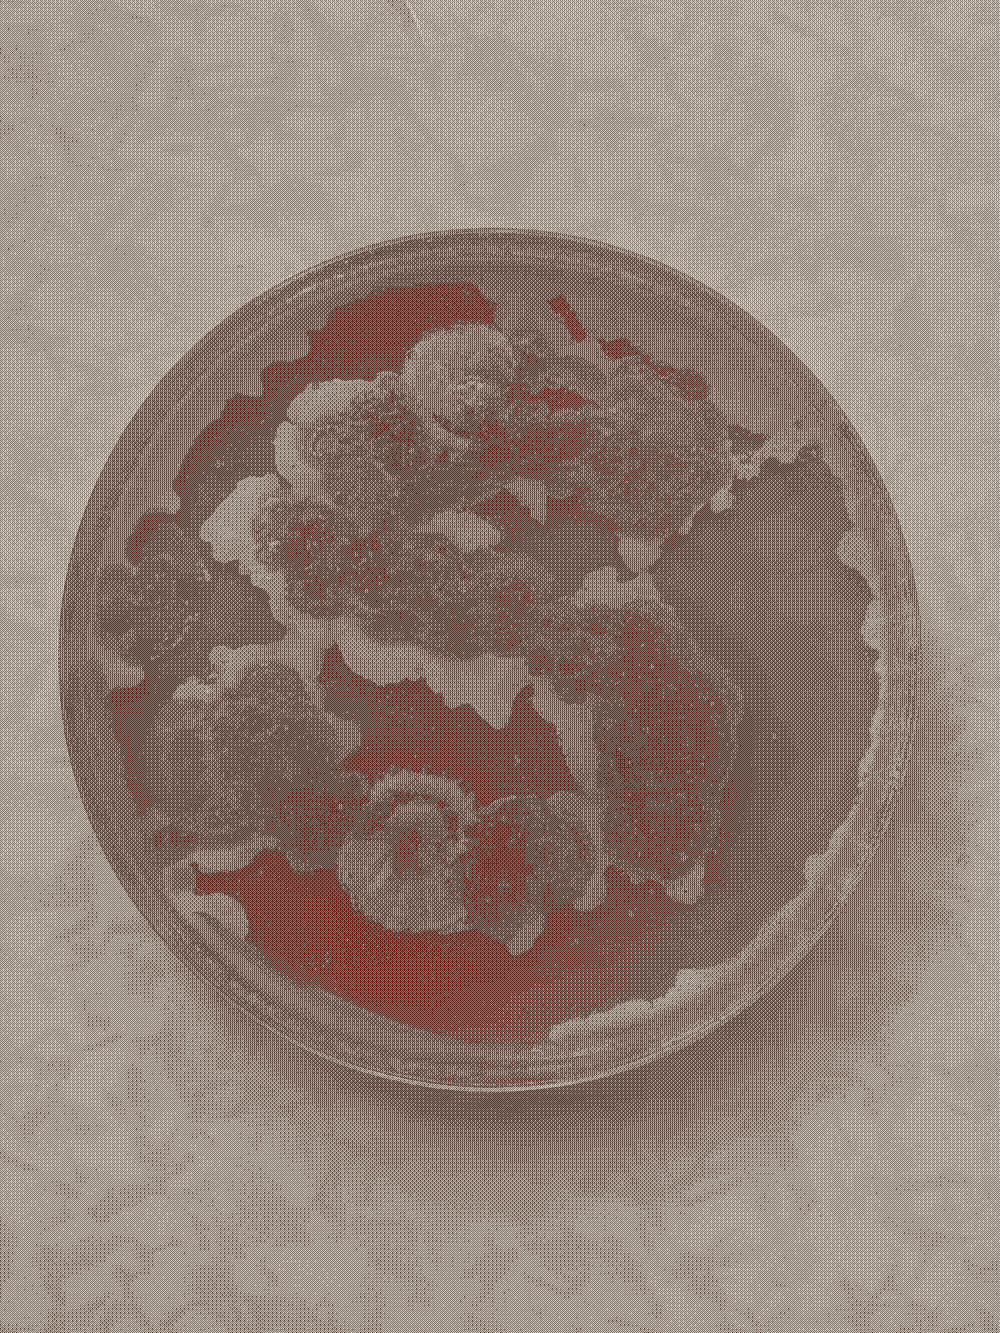
Petri-Typografie
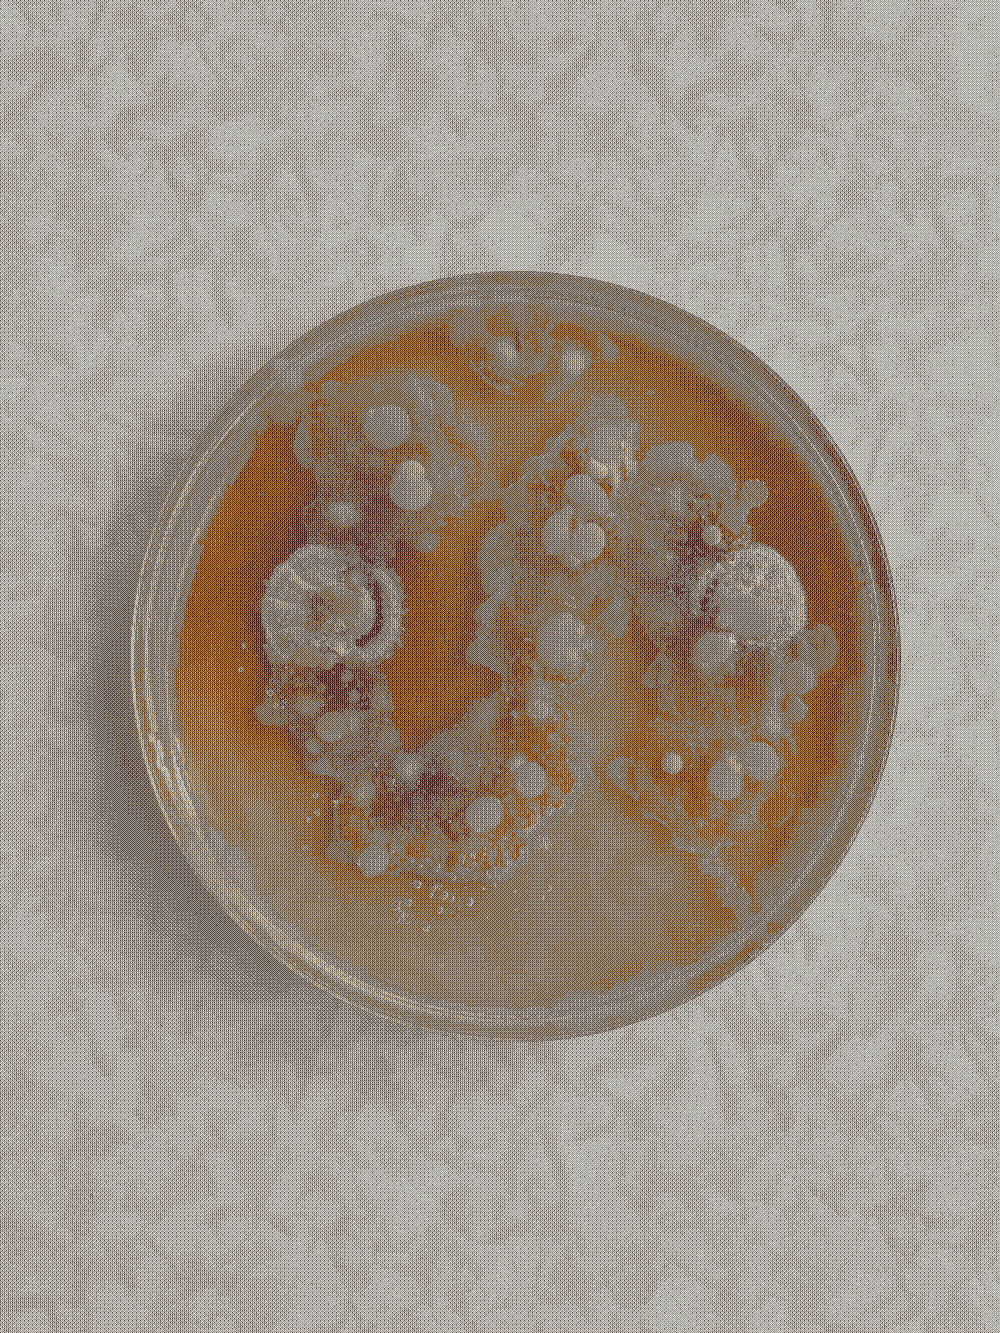
Petri-Typografie
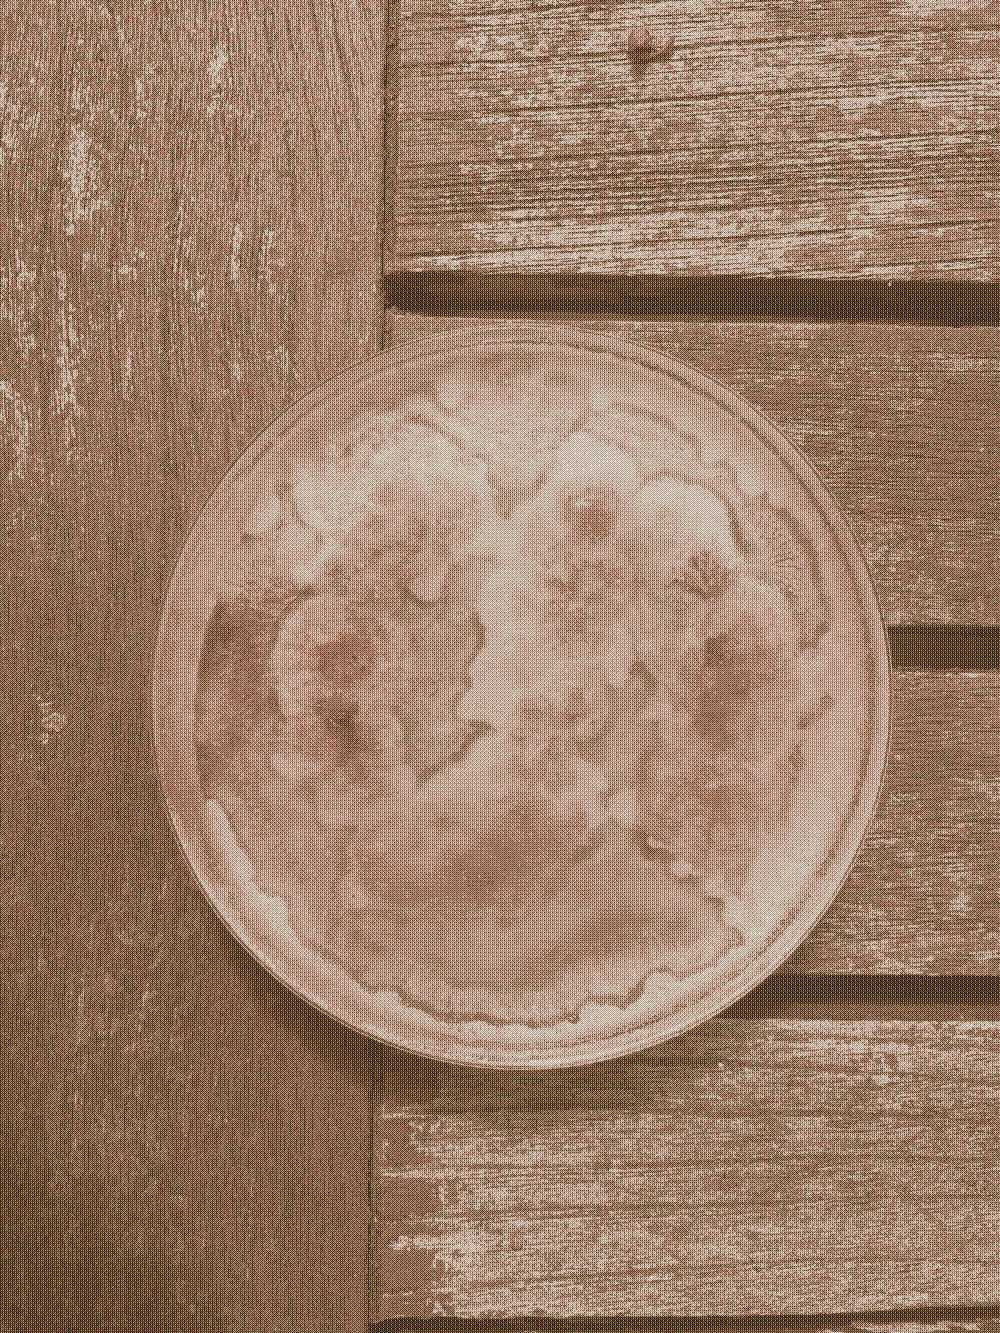
Petri-Typografie
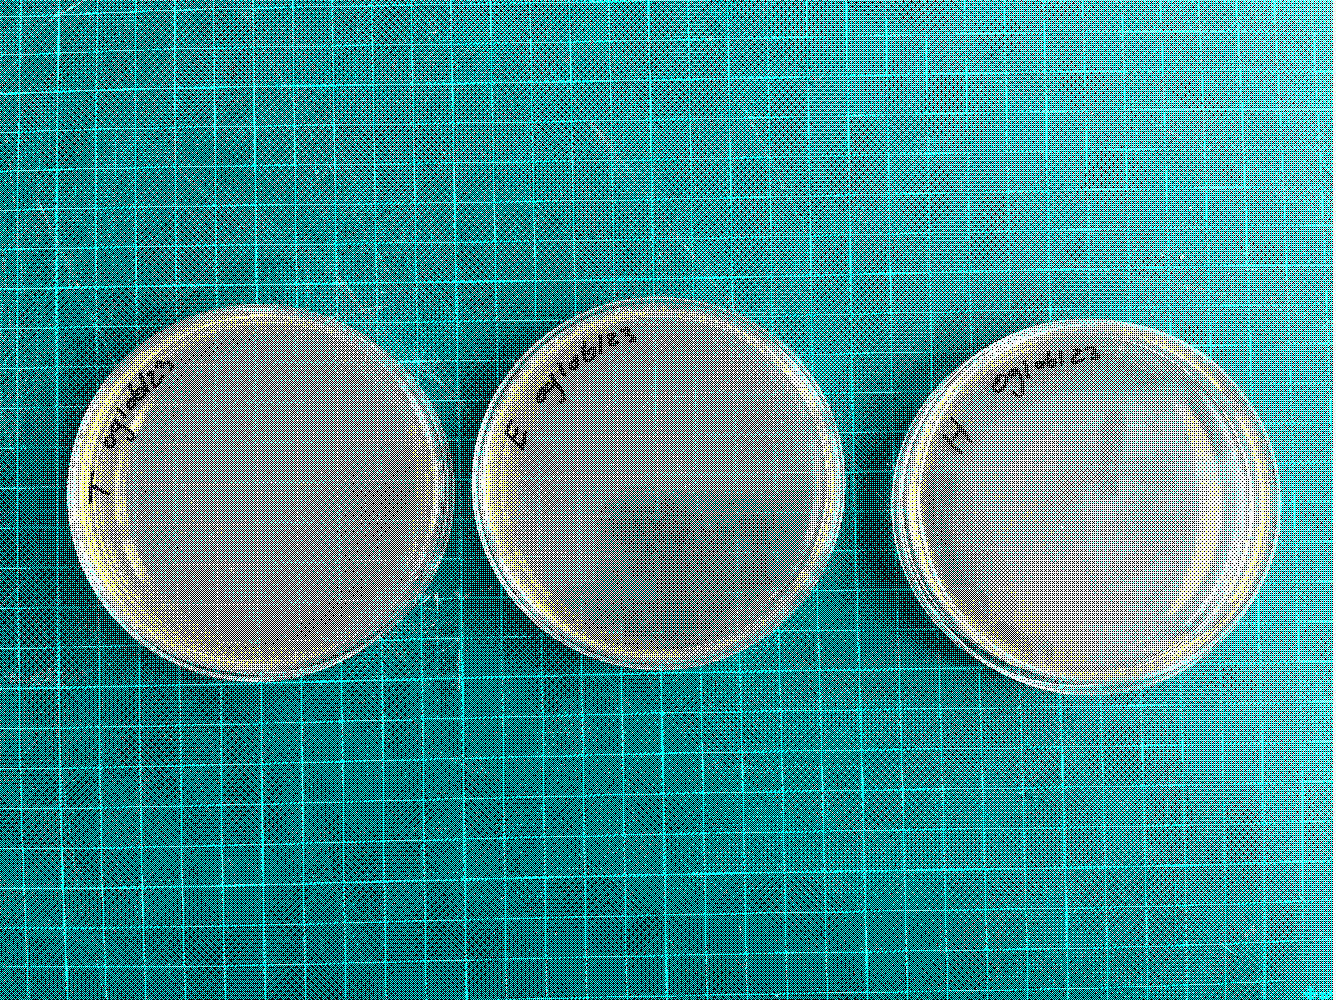
Petri-Typografie
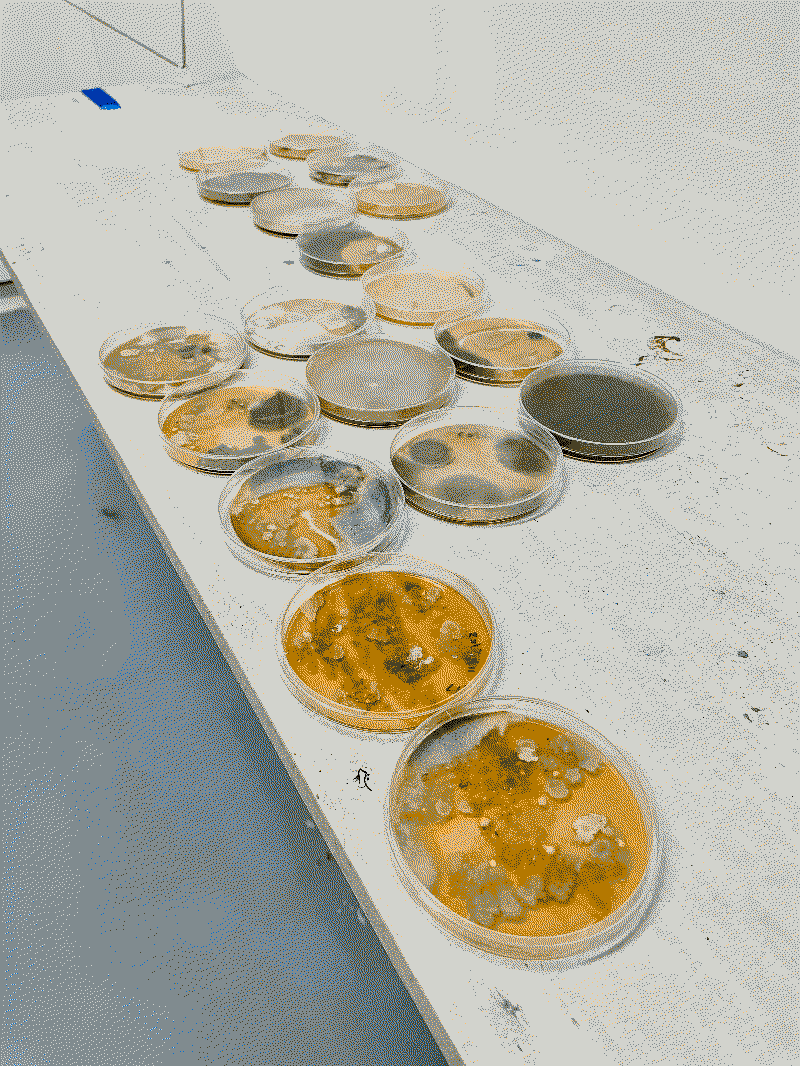
Petri-Typografie
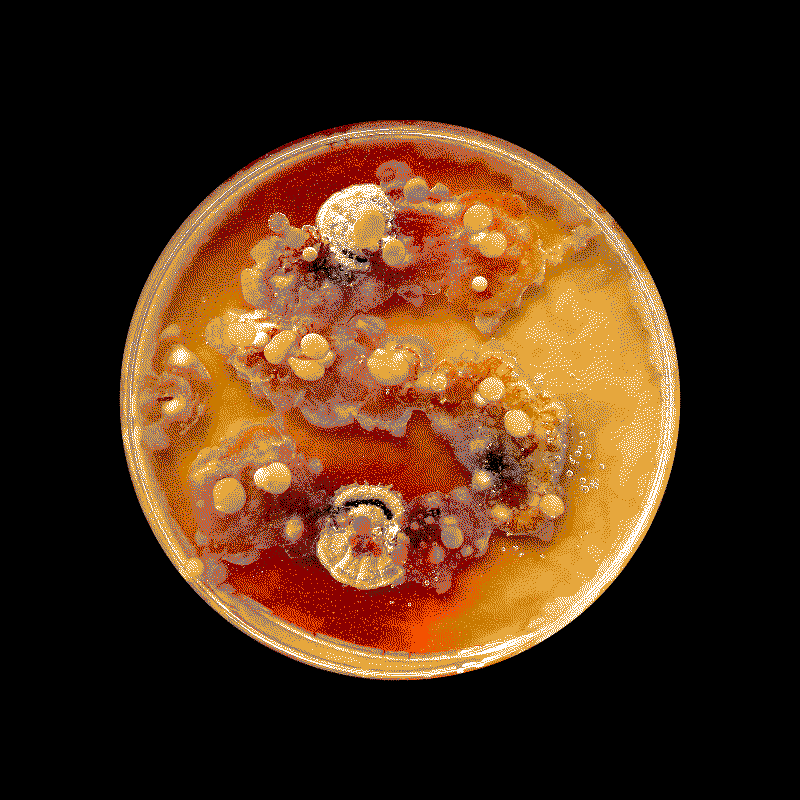
Petri-Typografie

Alle benodigheden voor het experiment
(1/2)

Alle benodigheden voor het experiment
(2/2)

The existence and acknowledgment of non-human entities are essential within the Symbiocene. The use of
petri dishes provides a simple way to visually represent the presence of these entities. By placing
petri dishes in a spatial context over a certain period, non-human entities can emerge over time.
This experiment focuses on creating typographic letters/images through the use of petri dishes. The
research is centred on the presence of non-human entities and the relationship between these entities
and the design process. It involves a form of co-designing with other-than-human entities.
Alle benodigheden voor het experiment
(1/2)

Alle benodigheden voor het experiment
(2/2)

By consciously allowing for interaction between human and non-human entities, a co-creation emerges
wherein new visual forms and meanings can arise. This experiment explores the possibilities of
collaboration with non-human actors and underscores the importance of their presence in shaping designs.
It opens the door to new perspectives and inspiring results that may otherwise remain unattainable.
To begin with, I formed an 'S' with my own finger - derived from the word 'Symbiocene' - and left it
standing for several days.
Dag 0
(1/6)

Dag 1
(2/6)

Dag 5
(3/6)
Dag 7
(4/6)
Dag 14
(5/6)
Dag 21
(6/6)
In the second example, the title of my project was written out. What was interesting about this attempt was that the result was different and more variable than in the first test. This is certainly not a negative outcome, but rather an illustration of the fact that as humans, we do not always have complete control. It demonstrates that there is no human sovereignty.
"H" Dag 0
(1/17)
"E" Dag 0
(2/17)
"T" Dag 0
(3/17)
"B" Dag 0
(4/17)
"E" Dag 0
(5/17)

"T" Dag 0
(6/17)
"A" Dag 0
(7/17)

"A" Dag 0
(8/17)
"N" Dag 0
(9/17)
"U" Dag 0
(10/17)
"I" Dag 0
(11/17)

"T" Dag 0
(12/17)

"A" Dag 0
(13/17)

"L" Dag 0
(14/17)
"L" Dag 0
(15/17)

"E" Dag 0
(16/17)
Overzicht Dag 0
(17/17)

The process of writing out the title has shown that there is room for unexpected variations and outcomes. This emphasises the interaction between humans and elements beyond our control, including non-human entities. Recognising this variability and embracing the diversity in results opens up new possibilities and perspectives within the design process.
"H" Dag 0
(1/2)
"E" Dag 0
(2/2)

This experience can teach us that as designers, we must collaborate with other-than-human entities and be open to the influences and forces that lie beyond our direct control. This allows us to make new and surprising discoveries and develop a deeper understanding of the symbiotic relationship between humans and other-than-human entities.
"H" Dag 8
(1/18)
-Typografie_13_Dag_8.webp)
"E" Dag 8
(2/18)
"T" Dag 8
(3/18)
"H" Dag 8
(4/18)
"E" Dag 8
(5/18)
-Typografie_8_Dag_8.webp)
"T" Dag 8
(6/18)
"T" Dag 8
(7/18)
-Typografie_9_Dag_8.webp)
"T" Dag 8
(8/18)
"T" Dag 8
(9/18)
-Typografie_10_Dag_8.webp)
"T" Dag 8
(10/18)
"U" Dag 8
(11/18)
"I" Dag 8
(12/18)
"T" Dag 8
(13/18)
-Typografie_16_Dag_8.webp)
"A" Dag 8
(14/18)
-Typografie_17_Dag_8.webp)
"L" Dag 8
(15/18)

"L" Dag 8
(16/18)
-Typografie_18_Dag_8.webp)
"E" Dag 8
(17/18)
-Typografie_15_Dag_8.webp)
"N" Dag 8
(18/18)
-Typografie_19_Dag_8.webp)
Throughout the process, there was a search for a suitable way to preserve the petri dishes effectively,
preventing bacteria and fungi from further growth. Experimentation was conducted with pouring epoxy into
the petri dishes to maintain the shape and achieve a pleasing presentation. Unfortunately, the result
was not as desired, as the epoxy caused a reaction with the nutrient medium, resulting in a white layer.
Additionally, consideration had to be given to the principles central to the Symbiocene, emphasising
collaboration between human and non-human entities and the use of environmentally friendly materials.
Therefore, it is important to explore alternative methods for preserving the petri dishes in a
sustainable and eco-friendly manner, aligning with the principles of the Symbiocene.
(1/8)

(2/8)

(3/8)

(4/8)

(5/8)
(6/8)
(7/8)
(8/8)
During the process, it became evident that the method I employed with the petri dishes has a timeframe
of approximately one month, during which the letter images are clearly visible. The images I had created
so far were no longer usable for my final presentation. To provide the audience with a good
visualization during my final presentation, I decided to rewrite my title.
In this experiment, I made an important adjustment that I should have applied during the previous
experiment as well. I stored the petri dishes that were not used in the refrigerator. This storage
option helps preserve the agar agar better, allowing me to maintain the quality of the images throughout
the entire process.
Parafilm om de petrischalen te sluiten
(1/6)

Aanraking
(2/6)

'Het'
(3/6)

'Het'
(4/6)

'Bestaan'
(5/6)

'Allen'
(6/6)
The final result of the research, which focuses on the presence of other-than-human entities and their relationship to the design process. Deliberately allowing space for interaction between human and other-than-human entities results in a co-creation that leads to new visual forms and meanings. This experiment explores the possibilities of collaboration with other-than-human actors and underscores their importance in shaping designs.
Final
(1/2)
Final
(2/2)